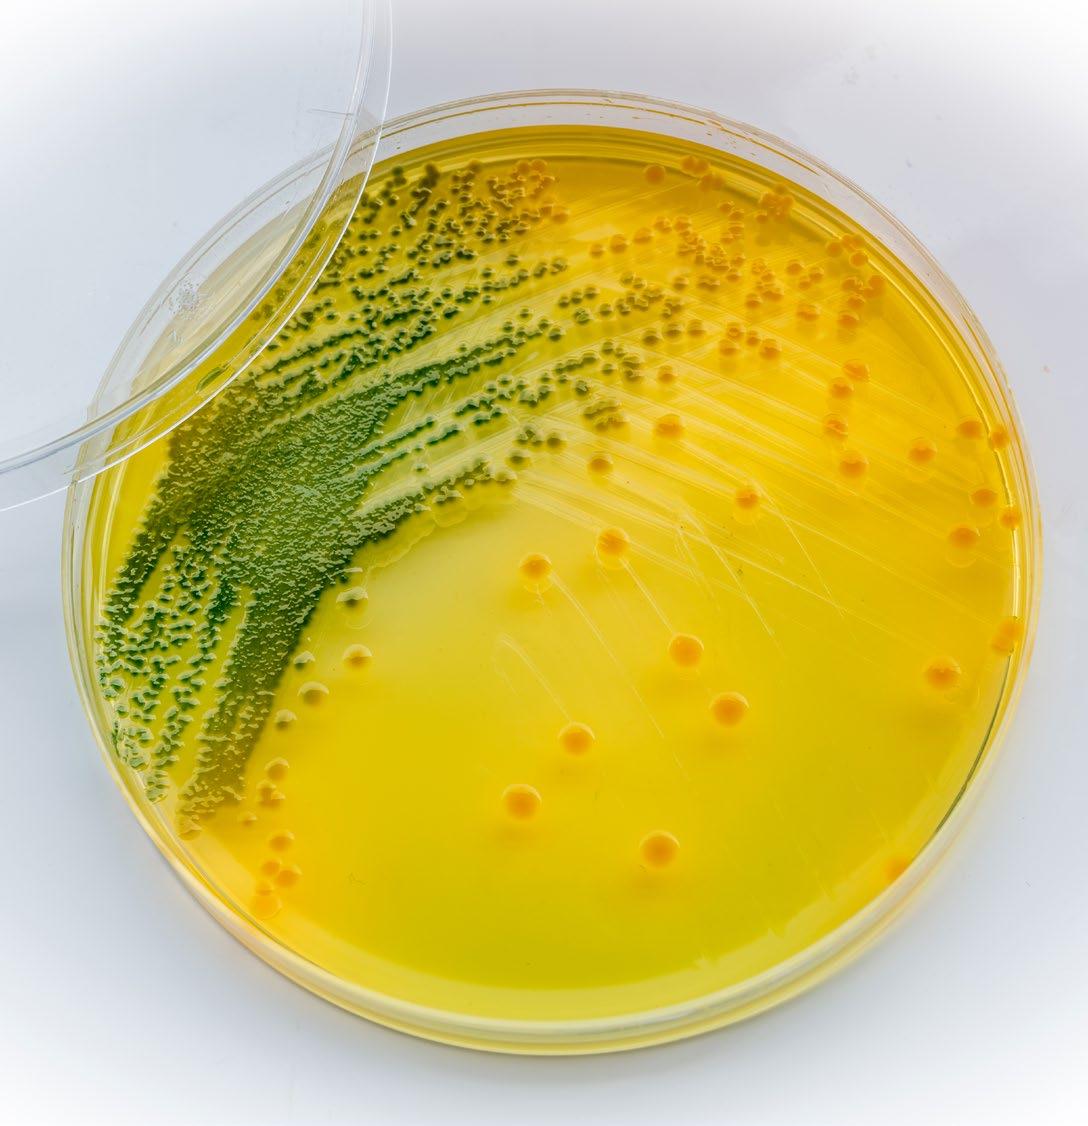

18 22 26
EDITOR´S COMMENTS
52
INDUSTRY NEWS
ARTICLE
Microorganisms in fish feeds, technological innovations, and key strategies for sustainable aquaculture.

GREENHOUSES AND POND LINERS
Marine microalgae commercial production improves sustainability of global fisheries and aquaculture.
ARTICLE
Mexican field trial shows clear potential for hatcheries to improve their bottom line.


ARTICLE
Internet of Things in aquaculture: a review of the challenges and potential solutions based on current and future trends.

UPCOMING EVENTS
ADVERTISERS INDEX
Editor and Publisher Salvador Meza info@dpinternationalinc.com
Contributing Editor Marco Linné Unzueta
Editorial Coordinator Karelys Osta edicion@dpinternationalinc.com
Editorial Design Perla Neri design@design-publications.com
Sales & Marketing Coordinator crm@dpinternationalinc.com
Sales Support Expert sse@dpinternationalinc.com
Operations Coordination Johana Freire opm@dpinternationalinc.com
Business Operations Manager Adriana Zayas administracion@design-publications.com
Subscriptions: iwantasubscription@dpinternationalinc.com
Design Publications International Inc. 401 E Sonterra Blvd. Sté. 375 San Antonio, TX. 78258 info@dpintertnatinonalinc.com
Office: +210 5043642
Office in Mexico: (+52) (33) 8000 0578 - Ext: 8578
Aquaculture Magazine (ISSN 0199-1388) is published bimontly, by Design Publications International Inc. All rights reserved. www.aquaculturemag.com
Follow us:
» 2 FEBRUARY - MARCH 2023 on
cover
INDEX Aquaculture Magazine Volume 49 Number 1 February - March 2023 Volume 48 Number 1 February - March 2023
the
Sustainable aquaculture ecosystem solutions in E-Commerce business: the case of eFishery.
6 4 12
32
44
COLUMNS
TECHNICAL GURU
The life of RAS…
CARPE DIEM
Flying with our feet on the ground... toward SMART aquaculture.
THE GOOD, THE BAD AND THE UGLY
What is the biggest disease issue facing shrimp farming today? AHPNS?



 By Stephen G. Newman Ph.D. * President and CEO AquaInTech Inc.
By Stephen G. Newman Ph.D. * President and CEO AquaInTech Inc.

» 3 FEBRUARY - MARCH 2023
38 42
48 THE FISHMONGER One step at a time.
By Amy Stone
By Antonio Garza de Yta, Ph.D.*
Marco Linné Unzueta Associate Editor
Fisheries and aquaculture contribute significantly to the well-being and prosperity of people around the world. According to FAO (2018), over the past 50 years, the global supply of fishery products for human consumption has outpaced the growth of the world’s population. Fish is now an essential source of nutritious food and animal protein for the majority of people, as well as a direct and indirect source of livelihood and income for a substantial proportion of the global population.
Therefore, it is essential to promote policies that allow the capitalization of all primary activities, with attention to the induction and productive conversion towards more efficient crops, species and technological packages that are more competitive in the markets, considering the need to integrate the aquaculture sector into the demanding dynamics of the global markets and the necessary modernization of the production and marketing facilities.
Without neglecting an exhaustive analysis aimed at defining the species to be promoted in the short term, we must emphasize the development of productive infrastructure, that is, the
Aquaculture, technology transfer challenges

generation of technologies on a permanent basis to promote aquaculture and especially mariculture. In this sense, it is necessary to address the validation of aquaculture production techniques and models that will contribute at the same time to the recovery of wild stocks and the development of productive activities of these species of high commercial value, as well as the improvement of farming equipment and methods, taking into account technological systems and state-of-the-art processes from the perspective of technological development.
It should be made clear that the technological advances to be studied, developed or transferred to the productive sector must be based on accurate, flexible and easy-to-use bioeconomic models that include sensitivity and risk analysis to determine the potential size of the market for added-value products, based on business plans with a broad economic and financial analysis, including a study of market dynamics and uncertainty, taking into account the following criteria:
9 Feasibility. Assessing the potential (technical, scientific, etc.) for
overcoming technological barriers: What is technically feasible? What can be achieved through research? How difficult is it to overcome the barrier?
9 Importance/relevance/urgency: How urgent is the need? How important is it to overall success to close this particular gap?
9 Socio-economic impacts. Economic and non-economic projections of expected benefits and consequences. Are the results broadly applicable or almost exclusively targeted? What is the relative return on the investment made to close a gap?
Accordingly, a formal and vigorous technology transfer program will be necessary to implement technological innovations with new and existing producers. The effectiveness of such a program will depend, in part, on the demonstration of technologies at an appropriate commercial scale to encourage their adoption, as well as performance verification programs that allow for evaluation and testing with cooperating producers to accelerate this technology transfer.
» 4 FEBRUARY - MARCH 2023

Second edition of Blue Food Innovation Summit will be held in London

The Blue Food Innovation Summit will once again be held in London to delve into the rapidly evolving landscape of aquaculture and ocean health. This time, the international event will take place on May 23 and 24 at the Hilton London Tower Bridge, bringing together ground-breaking companies from around the globe to discuss forward-thinking approaches to aquatic food production, including sustainable aquafeed, seaweed, fish health and welfare, and digital platforms for smallholder farmers.
By showcasing disruptive technologies and exploring case studies of innovation in action, the Blue Food Innovation Summit -that will have this year as slogan “Investing in sustainable aquaculture to replenish our oceans”-, aims to overcome barriers to growth and promote greater partnership and collaboration to protect and restore the ocean ecosystem, the organization explains.
From producers, feed suppliers and healthcare providers to retailers, investors and innovators, the Summit provides stakeholders from across the value chain with a vital platform for knowledge exchange and networking through interactive panels, breakout discussions, and quality 1-1 meetings.
Long list of conferences
With our food system increasingly under stress from conflict and climate change, the summit aims to put blue food, sustainable aquaculture, and restorative ocean practices at the heart of the global conversation.
The 2023 Summit discussions will focus on themes like “Ocean Data: Scaling Solutions in Restorative and Sustainable Ocean Management”, “Empowering Small-Scale Farmers: Accessing Digital Platforms, Finance and Certification” and “A Restorative Deep Dive: Optimizing Regeneration and Production in Restorative Ventures”.
Also, the specialist will speak about “Aquatic Health and Welfare: Enhancing Disease Prevention, Genetics and Harvesting”, “Expanding the Horizon for RAS: Fortifying Success Through Innovation in AI and Data” and “Blue Investment: Putting VC, ESG, and Growth Capital to Work in Today’s Financial Climate”.
Others issues about them will discuss will be “Sustainable Aquafeed: Utilizing Novel and Responsibly Sourced Marine Ingredients”; “Accelerating the Seaweed Revolution: Driving Innovation Across the Supply Chain” and “Unlocking Blue Carbon: Carbon Neutrality and Deep Blue Carbon Regeneration”.

Notable speakers
Between the notable speakers of the Blue Food Innovation Summit will be Amy Novogratz- Managing Partner, from AQUA-SPARK; Jennifer Bushman- CMO, Kvaroy Arctic; Ohad Maiman- Founder and CEO, The Kingfish Company; Jorge Diaz- Head of Sustainability, from Skretting; Laurent Develle- EVP Group General Counsel and Head of Corporate Affairs, from Regal Springs.
Also, will offer their knowledge Briana Warner- CEO, Atlantic Sea Farms; Liris Maduningtyas- CEO, JALA TECH; Thor Talseth- Group Chief Executive Officer, Avramar; Christian Lim - Managing Director, Swen Capital Partners; Melanie Siggs - Director of Strategic Engagements, Global Seafood Alliance; and Nathan Pyne-Carter- CEO, Ace Aquatech.
Finally, will speak Robert JonesGlobal Lead Aquaculture, The Nature Conservancy; Benjamin Weis- Aquaculture Manager, from TESCO; Markus Müller- Managing Director, Chief Investment Officer ESG & Global Head of Chief Investment Officer Private Bank, Deutsche Bank; Brian Tsuyoshi Takeda- Founder and CEO, URCHINOMICS; Chris Gorell Barnes- Founding Partner, Ocean 14 Capital; and Catarina Martins, Chief Technology and Sustainability Officer, Mowi.
The organization highlights in their website the Summit offers “two actionpacked summit days”, the presence of 350 delegates and six weeks networking and content. For more information those interested may visit www.bluefoodinnovation.com.
» 6 FEBRUARY - MARCH 2023 INDUSTRY NEWS
Royal DSM and Foundation Earth announce agreement to cooperate on eco-labeling of food
Royal DSM, a global purpose-led science-based company, and Foundation Earth, an independent and non-profit organization issuing front-of-pack Eco Impact scores on food products, announce their agreement to cooperate on eco-labeling of food and beverages to empower consumers to make more sustainable food choices based on transparent and credible information.
The agreement means that agri-food companies joining Foundation Earth can now access DSM’s Sustell service to measure and improve the environmental impacts of animal protein products (e.g. fish, eggs, milk and meat), based on accredited methodologies (e.g. EU PEF).

Within the new partnership DSM will undertake full Life Cycle Assessments (LCAs) for participating brands under the Foundation Earth method, enabling companies to access an aggregated eco impact score on their food and drink products, as well as an ecolabel that can be displayed on the frontof-pack. The scores delivered by Foundation Earth range from A+ to G and are re-certified yearly, making it possible for product owners to improve their production and grade over time.
Helping producers to achieve sustainability commitments
Developed by DSM with Blonk Consultants, Sustell is a first-of-its-kind intelligent sustainability service that delivers accurate, simple, and actionable farm-level solutions to improve animal protein production’s environmental footprint and profitability. By catalyzing sustainable value chains and enabling environmental transparency and supply chain to differentiate, Sustell helps producers achieve their sustainability commitments.
Cliona Howie, CEO at Foundation Earth, Foundation Earth: “At Foundation Earth we are always looking to extend our knowledge by partnering with diverse experts in the food sector. We
are excited to join forces with DSM, who will allow us to scale our work and bring further expertise on Life Cycle Assessments for protein under the Foundation Earth method.”
In the other hand, Ivo Lansbergen, Executive Vice President of Animal Nutrition and Health at DSM: “I firmly believe that nutrition and sustainability information are essential for consumers to make informed decisions. Primary, farm-level data is key to enabling all the players in the animal protein value chain to unlock new market opportunities and create a race to the top in terms of sustainability. Sustell makes it possible.”
A company founded in 1902
It’s good to remember that Royal DSM is a global, purpose-led company in Health, Nutrition & Bioscience, applying science to improve the health of people, animals and the planet. DSM’s purpose is to create brighter lives for all. DSM’s products and solutions address some of the world’s biggest challenges while simultaneously creating economic, environmental and societal value for all its stakeholders – customers, employees, shareholders, and society at large. The company was founded in 1902 and is listed on Euronext Amsterdam. More information can be found at www.dsm.com.
In the case of Foundation Earth, is an independent, non-profit organization issuing front-of-pack environmental scores on food products, helping businesses build a more resilient and
environmentally sustainable food system while giving consumers the tools they need to make sustainable buying choices.
DSM-Firmenich merger at Extraordinary General Meeting
In the beginning of this year, Royal DSM held an Extraordinary General Meeting of Shareholders (EGM). The DSM Shareholders approved the proposed merger between DSM and Firmenich International and voted in favor of all related resolutions as set out in the notice of the EGM.
“This is a momentous day in the long history of DSM. We are grateful for our shareholders’ strong support for this merger as we seek to build the leading creation and innovation partner in nutrition, beauty and well-being. There are powerful synergies from bringing together DSM and Firmenich that can deliver superior growth. DSMFirmenich will be uniquely positioned to best anticipate and address the changing needs of consumers, unlocking new opportunities that benefit our customers, our people, and the wider world,” commented Geraldine Matchett and Dimitri de Vreeze, Co-CEOs of DSM
Firmenich International creates fragrances, flavors and ingredients to delight the senses. They have been innovators in the science of the senses since 1895. Today, with more than 11,000 colleagues in their global family, they are the largest privately-owned fragrance and taste company in the world.
» 7 FEBRUARY - MARCH 2023
Registration
is now open for the
second annual Global Shrimp Forum
that will take place in Utrecht, Netherlands.
The registration period for the second World Shrimp Forum, to be held in Utrecht (The Netherlands), is now open.
The Global Shrimp Forum has announced the opening of registration for its second annual event. The forum, which takes place between 5th-7th September at the Van der Valk Hotel, Utrecht (Netherlands) will welcome over 400 high-level executives from across the globe, representing the entire shrimp value chain, farmers, feed companies, technology suppliers, service providers, processors, exporters, importers, wholesalers, retailers and other industry stakeholders.
Willem van der Pijl, joint Founder of the Global Shrimp Forum said, “We are delighted to share the news
that the Global Shrimp Forum is returning for its second event in 2023 and that early-bird registration is now open! Preparations for this year’s event are well underway, and we are thrilled to announce that more than 35 companies have already confirmed as sponsor for this year, including Aqua-Spark, Avanti, Chicken of the Sea, Devi Seafoods, Maruha Nichiro, Minh Phu Seafood Corporation, Omarsa, Rabobank, Sandhya Aqua, Seafood Connection, Skretting, Songa, Thai Union, Vitapro, and many others.”
“We were overwhelmed by the amount of positive feedback we re-
ceived from 2022, with 98% of the 160 attendees we surveyed rating the forum as 4 or 5 stars out of 5. We can’t wait to welcome previous and new attendees to the forum this year and do even better,” he added.
Fantastic array of speakers
Last year’s event covered a whole range of topics and featured a fantastic array of speakers, with seminars covering Innovation and Technology, Market and Retail Outlook and Legal and Regulatory Challenges within the Shrimp Industry.
According to the organization, the 2023 event is set to be even bigger

» 8 FEBRUARY - MARCH 2023 INDUSTRY NEWS
and better, featuring an improved program with seminars spread across all three days and more detailed Q&A sessions. The forum will once again provide over 25 hours of fascinating, high-quality content and offer delegates the chance to network with existing and new peers from across the industry.
Regarding the program of the World Shrimp Forum 2023, its website reports that it will be announced in the second quarter of 2023.

The second edition of the Global Shrimp Forum will be held at the Van der Valk Hotel Utrecht, the Netherlands. Traveling from Amsterdam Schiphol Airport or Amsterdam Central Station to the Van der Valk hotel in Utrecht is only a


short journey. So, the assistants can plan their stay in Utrecht, close to the venue, or in Amsterdam.
It’s good to know that early-bird registration is now open until 1st April, so be sure to register your place via the Global Shrimp Forum website to ensure you don’t miss out.
The place where industry leaders come together to discuss Established by the Aquaculture Stewardship Council, Shrimp Insights and Contango, the Global Shrimp Forum Foundation is an independent non-profit and mission-oriented organization based in Utrecht the Netherlands. The Global Shrimp Forum is the place where industry leaders come together to
discuss the most pressing issues their businesses are confronted with and to develop a vision on the longterm strategy towards a resilient and sustainable industry. GSF aims to facilitate dialogue and encourage collaboration, they explain.
In 2022, at the inaugural edition, they gathered with more than 430 people representing over 225 companies and 33 countries. They had 2.5 days of content, networking and celebration. “The feedback we received was overwhelmingly positive and it was clear that the warm water shrimp industry had been waiting for its own leadership venue. With support from our partners, we are certain that we will now let the Global Shrimp Forum grow to the next level,” they said.
» 9 Aquaculture Magazine FEBRUARY - MARCH 2023
A new study, conducted in collaboration with Professor Åshild Krogdahl and Associate Professor Trond Kortner at the Faculty of Veterinary Medicine at the Norwegian University of Life Sciences and Aker BioMarine, concludes that krill meal and krill oil fulfill the dietary choline needs for growth in farmed Atlantic salmon.
Antarctic krill in both its meal and oil forms is a natural and sustainable source of several important nutrients for fish, including phospholipids, omega-3 fatty acids, astaxanthin and choline. The researchers behind this study set out to evaluate whether choline from krill meal or krill oil as part of the dietary feed could help alleviate intestinal steatosis, called lipid malabsorption syndrome (LMS) in severe cases.
Why do fish need choline?
· Choline is an essential nutrtient for both humans and animals and is typically obtained through the diet.
· It supports healthy liver, brain and muscle function, and it is important for cell inttegrity aas well as the trtansport of fat in the body.
· When fish have a choline deficiency, too much fatt builds up in the intestines ratcher than being transported and absorbed. This can be harmful to the fish growth and health.
What is lipid malabsorption syndrome (LMS) and how does it affect fish?
· LMS is a severe condition that occurs when choline levels are too low in the fish.
· It results in a buildup of fats or lipids in intestine.
· Excessive fatty deposits in the intestine or liver of the fish can harm the fish health and reduce its overall quality as a consumer product.
“Choline is an important nutrient that is necessary for health and growth in fish. It also influences intestinal health. In our research with the Norwegian University of Life Sciences, we, tested whether choline from krill could reduce the buildup of excessive lipids in the intestine, causing LMS, which is detrimental to fish health and growth,” says Dr. Kiranpreet Kaur, Director R&D Fish Health and Nutrition, Aker BioMarine, and a corresponding author of this study.
Researchers set up an 8-week trial with Atlantic salmon, testing six different diets
The 56-day feeding trial was conducted on-site at the Center for Fish Research at the Norwegian University of Life Sci-
ences campus in Ås, Norway. This study marks the first time that the unique choline type found in krill, called phosphatidylcholine, was evaluated for its effect on reducing intestinal steatosis in salmon. The krill ingredients for the study were provided by Aker BioMarine, from the QRILL™ Aqua product line. During the trial, a total of six different diets were formulated, including a reference diet with no choline supplement, two diets with krill oil and another two with krill meal, each at varying levels. The sixth diet was supplemented with inorganic form of choline, choline chloride, at a high level. The full study can be found here: https://www.hindawi. com/journals/are/2023/4001633/
Key findings
9 The study showed the high and similar ability of both krill meal and krill oil to reduce lipid (fat) accumulation in the salmon intestine, thus reducing the likelihood of intestinal steatosis and/or lipid malabsorption syndrome.
9 In a similar way, choline at lower inclusion levels from both krill meal and krill oil reduced lipid (fat) accumulation in the salmon liver to the same extent as the positive control group.
9 The krill meal and krill oil diets showed a growth stimulating effect in comparison to highly choline deficient diets.
9 Salmon growth was significantly higher in the krill meal and krill oil groups consuming 2.6g/kg of choline, in comparison to the positive control group, indicating that even sub-optimal levels of choline can satisfy choline needs for growth.
“What we learned from this study is that choline from krill meal and krill oil is equally effective, even at lower inclusion levels, in stimulating growth in fish and in supporting better intestinal
and liver health,” says Sigve Nordrum, EVP Animal Health and Nutrition, Aker BioMarine. “Our findings prove that krill is a functional ingredient that can significantly improve the nutritional quality of the dietary feed, leading to better quality products.”
About QRILL™ Aqua
QRILL™ Aqua brand consists of sustainable and natural krill derived ingredients for aquaculture feeds. The main product, QRILL™ Aqua Total, is a cost-effective ingredient with a valuable package of nutrients and attractants. Documented through science on both fish and shrimp, QRILL™ Aqua Total keeps demonstrating increased appetite and growth. It is also proven to enhance robustness through improvement of several health parameters, as well as improving fillet quality. More information is available atwww. qrillaqua.com.
About Aker BioMarine
Aker BioMarine is a biotech innovator and Antarctic krill-harvesting company, dedicated to improving human and planetary health. Listed on Oslo Stock Exchange, the company develops krillbased ingredients for pharmaceutical, nutraceutical (Superba®, NKO® and K·REAL®), aquaculture (QRILL™ Aqua), and animal feed applications (QRILL™ Pet), including INVI™, a highly concentrated protein isolate, and LYSOVETA™, a targeted transporter of EPA and DHA from krill. Aker BioMarine’s fully transparent value chain stretches from sustainable krill harvesting in pristine Antarctic waters through its Montevideo logistics hub, Houston production plant, and to customers around the world. The company’s strong focus on sustainability inspired the launch of AION by Aker BioMarine, a circularity company dedicated to helping companies to recycle and reuse waste. Read more: www.akerbiomarine. com
» 10 FEBRUARY - MARCH 2023 INDUSTRY NEWS
New study shows krill diets fulfill choline requirements and prevents fat accumulation in intestine and liver in farmed Atlantic salmon
Norwegian Pure Salmon Kaldnes adds Jon Pedersen to its team, ex Global Head
of Engineering in AKVA group Land Based
The company based in Sandefjord (Norway), Pure Salmon Kaldnes, has announced that Jon Pedersen is now part of their team as a member of the company’s Aquaculture Competence Centre. The new asset of the company from last 1st of December comes from a position as Global Head of Engineering in AKVA group Land Based. CEO at Pure Salmon Kaldnes, Kent Kongsdal Rasmussen assured that is very pleased to have Pedersen on board. “We are a company that supplies complete solutions within the RAS industry and our customers are among the most progressive and most demanding. We therefore need to have an organization with skills that can match this.”

Meanwhile and according with his declarations in a press release of Pure Salmon Kaldnes, Pedersen’s broad experience from the aquaculture industry will be very useful in Pure Salmon Kaldnes. “I think there is an exciting development in the industry right now, and I chose Pure Salmon Kaldnes because they are a dynamic company that dares to think new. It is really close to my heart to be involved in building an organization and structuring it in a targeted and efficient way, like I will here in Pure Salmon Kaldnes,” he said. “During my time at AKVA group, I have had an exciting job where I have been project manager on, among other things, the Bakkafrost Strond project in the Faroe Islands. This was a large project that consisted of nine RAS departments. In the last year as Head of Engineering I’ve worked on building a professional engineering organization as well as equipping it for future growth,” Pedersen added.
New office in Fredericia
In the other hand, and as part of Pure Salmon Kaldnes new strategy, they are opening an office in Fredericia, Denmark, in 2023. Pedersen will be a central part of the team that will work there and reveals that part of the reason for starting in the company is to help build up the company’s new office, with all the exciting opportunities it offers in Fredericia.
In that sense, Rasmussen concludes: “Since 8F and Pure Salmon’s takeover of the company in the summer of 2021, we have undergone a major change and development. We have doubled the number of employees and started internationalization, which means that we will be in additional markets; we therefore need offices outside Norway. The first step is Denmark. It makes good business sense to open an office in Denmark, the driving force behind this decision is access to experience and expertise. The office in Denmark will be closely integrated with the offices in Norway and the UAE.”
RAS- technology sustainable and customized
Pure Salmon Kaldnes is consultant, contractor and supplier of equipment and services, both locally and globally. The RAS- technology they offer is sustainable and customized for each fish farm, they assure.

In 2021 the aquaculture division of Krüger Kaldnes was separated from the company and sold to the international group 8F Asset Management. It was merged with Pure Salmon Limited and named Pure Salmon Kaldnes. 8F Asset Management has invested in large land-based farming facilities in the US, Poland, France and Japan, and they are already planning other comprehensive land-based farming projects, for instance in China and South Africa. “We have delivered 19 facilities and contributed at a dozen other facilities, including two of the largest smolt facilities in the world: Helgeland Smolt and Lerøy Sjøtroll. Now we will also deliver construction to the world’s largest fish hatchery in Tjuin, Norway, owned by one of the world’s largest producers of farmed salmon, SalMar,” they say.
The aquaculture division has been a contributor in revolutionizing land-based aquaculture during the last 20 years, continuously focusing on fish welfare. 2With our expertise we strive to develop innovative solutions and contribute to our owners’ goal to produce 260,000 tons of Atlantic salmon every year”, they say.

» 11 FEBRUARY - MARCH 2023
Microorganisms in Fish Feeds, Technological Innovations, and Key Strategies for Sustainable Aquaculture
Aquaculture feeds include fishmeal and fish oil, extracted from wildcaught fish such as sardines, and poses ecological, food security, and economic drawbacks. Here is a review on the recent development of using microorganisms, technological innovation, challenges, and opportunities to develop a low environmental footprint of aquaculture diet.
By: Aquaculture Magazine Editorial Team*
Aquaculture, the fastest growing food sector globally (8% average production increase/yr. for 1970–2014), now produces about half of all fish for human consumption, as global capture fisheries have reached or exceeded their sustainable limits and plateaued at~90 million tons/yr. Aquaculture is the world’s most efficient protein generator and will play a key role in solving the grand challenge of feeding more than 9 billion people by 2050 by meeting the escalating demand for water, energy, and food while conserving environmental resources and protecting livelihoods.
Fed aquaculture grew 158% from 2000 to 2018 when it comprised nearly 60 million MT of production. The production of aquaculture feeds for the fed aquaculture is likewise expected to increase, and 73.15 million tons of feeds are projected to be used by 2025.
The environmental impacts and increasing price of aquaculture feed (aquafeeds) constrain U.S. aquaculture development. Feed has the largest overall environmental impact along the supply chain of intensive fed aquaculture, wherein the yields depend on giving animals nutritionally complete formulated feeds. The environmental sustainability of aquaculture food production systems is of critical concern due to its rapid expansion.
Among the parameters that contribute to the overall environmental impacts, aquafeed was identified as an impact hotspot, and the production of feed ingredients contributed most to the global warming potential and other emissions.
Use of Fishmeal and Fish Oil in Aquafeed
Unfortunately, the fishmeal (FM) protein and fish oil (FO) ingredients in current commercial aquaculture feed (aquafeed) come from unsustainably
sourced marine forage fish that are core components of marine food webs. Currently, aquafeeds use more than 70% of the world’s fishmeal and fish oil, which are rendered from small wild-caught forage fish (such as herrings, sardines, and anchovies). Globally, approximately 16.9 million of the 29 million tons of ocean-caught small fish are currently used for aquaculture feeds each year.
Even with the diminishing inclusion of fishmeal in aquaculture feeds, an estimated shortage ranging from 0.4 to 1.32 million metric tons of fishmeal could occur by 2050, significantly impairing the aquaculture industry growth. Analysts also projected that at the current rates of FM and FO consumption, aquaculture feed demands could outstrip the supply of forage fish by 2037, with disastrous consequences for the food security of billions of humans and for wild marine fish, mammals, and seabirds that forage on them.
» 12 FEBRUARY - MARCH 2023 ARTICLE
Use of Terrestrial Crops and Oils in Aquafeeds and Environmental Challenges
Aquafeed manufacturers currently over-rely on terrestrial crops (e.g., soy, corn, canola) to replace fishmeal and fish oil; these would otherwise feed livestock or people. Industrial agriculture is facing a tremendous challenge due to agricultural pollution resulting in a loss of arable land. The increasing demand for these crops by aquaculture’s explosive growth could elevate the environmental problems that are caused by farming them, including high nutrient and chemical inputs, runoff that increases eutrophication, the clearing of sensitive lands (e.g., in Amazonia), high energy inputs, and greenhouse gas emissions. However, typically, the cultivation of terrestrial crops such as transgenic soy requires a large volume of water, pesticides, and fertilizers, and these also cause the deforestation of areas with high biological value.

Also, terrestrial plant protein and oil ingredients have several nutrition-
al disadvantages such as a low nutrient digestibility due to high levels of antinutritional components, and a deficiency in limiting essential amino acids, for example, lysine, methionine, threonine, and tryptophan. Replacing FM protein with terrestrial crop protein remains a significant challenge for the industry and has stimulated compensatory research such as adding single amino acids to provide missing essential amino acids.
In terms of the nutritional disadvantages of terrestrial crop oil, longchain polyunsaturated fatty acids (LCPUFA) such as docosahexaenoic acid (DHA) and eicosapentaenoic acid (EPA) are the major limiting fatty acids acid in terrestrial crop oils. These are the essential omega-3 fatty acids for salmonids, and the requirement is around 0.5–1.0% of the diet.
The composition of omega-3 and other nutrients in farmed fish species has been altered, and this affects human nutrition, as there are decreases in the mineral concentration of iodine, selenium, vitamin D,
and most significantly, omega-3 fatty acids in fish fillet. High percentages of vegetable oils in aquafeeds alter fish muscle fatty acid composition, notably reducing omega-3 such as docosahexaenoic acid (DHA) and eicosapentaenoic acid (EPA), which aids with cardiovascular, cognitive, and neural development and provides other human health benefits. Partially or totally replacing fish oil with crop oil also unfavorably changes the flesh fatty acid composition in many fish species. Over the past decade, the beneficial EPA and DHA content in farmed salmonids fillets has significantly declined, mainly due to the higher inclusion of vegetable oils in aquafeeds (Figure 1).
Novel Aquafeed Ingredients Microalgae Protein and Oil
The industrial-scale production of microalgae has gained momentum for their use in aquaculture feeds. Marine microalgae particularly have potential to replace fishmeal and fish oil in salmonids and other finfish
» 13 FEBRUARY - MARCH 2023
feeds because of their high levels of fatty acid and protein content. Marine microalgae, Nannochloropsis oculata, Isochrysis sp., and Schizochytrium sp. showed promise in aquafeed because they are rich in EPA, DHA, protein, key amino acids (methionine and lysine), lipids, and are good sources of minerals. A recent study showed that Isochrysis sp. is a highly digestible protein, amino acid, lipid, and fatty acids source for rainbow trout (Table 1). This species could be a good candidate for fishmeal and fish oil replacement in rainbow trout diets and can be used as a health-promoting omega-3, DHA supplement in diets.
A recent study showed promise in developing a fish-free feed for rainbow trout by combining marine microalgae Nannochloropsis sp., Isochrysis sp., and Schizochytrium sp.; the detected fillet DHA levels were similar (Figure 2).

In addition, the cultivation conditions of microalgae, for example, light, temperature, and nutrient source, can also impact the phototrophically grown microalgal composition, including the fatty acid composition. It ultimately affects the consistent quality of the final product. There has been extensive research on the capabilities of heterotrophic algae oils and their success in commercial trials. A number of aquafeed companies have recently begun commercially producing DHA-rich oil from Schizochytrium sp. for salmon feeds.
Yeast, Fungi, and Bacteria
Saccharomyces cerevisiae, various Aspergillus, and Fusarium venenatum are widely known, but other strains such as Candida utilis, Candida, Hansenula, Pichia, Torulopsis, and Kluyveromyces marxianus are also stimulating interest as protein ingredients for aquaculture feed. Several yeast meals, for example, S. cerevisiae, Candida utilis, and K. marxianus have been used in salmon feeds. Candida utilis and K. marxianus are good sources of protein and could substitute up to 40% of the fishmeal without compromising growth.
However, S. cerevisiae was reported as a poor protein ingredient for fish feed.
Some bacterial strains can play an important role in producing very high crude protein contents (approximately 60 to 82% of dry cell weight) and essential amino acid levels, along with vitamins, phospholipids, and other functional compounds.
There is great potential to produce bacterial protein, but more organisms need to be identified for commercial scale production. It is interesting to note that the bacteria can be cultured on agricultural wastes (rice straw, rice hulls, manure, and starchy residue), as the substrates attain a high level of protein. Additionally, bacterial proteins contain other nutrients including lipids, vitamins, and minerals. Although bacterial proteins are very attractive for future aquafeed, the challenges associated with pro-
cessing, the economy of scale, and their adoption globally need to be addressed.

Insect Meal
The aquafeed industry is actively seeking a diverse array of alternative feed ingredients for fishmeal, including insect meal. Insects could provide a sustainable source of protein for aquacultures using food waste. As of now, the following species are the most studied for producing protein meals, and they account for the majority of the literature: black soldier fly, common housefly, yellow mealworm, lesser mealworm, house cricket, banded cricket, and field cricket. Among these species, the black soldier fly (Hermetia illucens, L.; BSF) is considered the most attractive insect meal for aquafeed for salmonids, i.e., rainbow trout (Onchorhynchus mykiss) and Atlantic salmon (Salmo salar).
» 14 FEBRUARY - MARCH 2023
ARTICLE
Several studies have shown promise with the use of insect meals in aquafeeds, and the inclusion of insect meals is still a recent development, with many uncertainties existing that could influence whether the aquafeed industry adopts insect meals on a large scale.

Fish Processing Byproduct
The processing of fish for human food generates byproducts such as heads, viscera, frames, skins, and oth-
ers, such as tails, fins, scales, mince, blood, etc. These byproducts are actually good sources of protein and oil, from which fishmeal and fish oil can be yielded. Fish-processing byproducts are still not fully utilized. Approximately 25–35% of fishmeal comes from the byproducts of fish processing. Approximately 10% of byproducts are generated by aquacultures, 19% of byproducts are generated by capture fisheries, and 71% of byprod-
Marine microalgae particularly have potential to replace fishmeal and fish oil in salmonids and other finfish feeds because of their high levels of fatty acid and protein content.

ucts are generated by whole capture fisheries.
The largest volume of fish processing waste is produced in North America and Oceania. Fish wastes are mainly generated in the global south, mainly due to a lack of highquality ice, cold storages, and refrigerated transportation. Capturing fish processing byproducts is often not economically viable due to logistic and technical constraints.
» 15 FEBRUARY - MARCH 2023
Bacterial proteins are very attractive for future aquafeed, the challenges associated with processing, the economy of scale, and their adoption globally need to be addressed.
Key Strategies to Measure Nutritional and Environmental Sustainability Ingredients Digestibility
The digestibility of aquafeed ingredients is key information for formulating economically viable and environmentally responsible feeds, but limited digestibility data are publicly available for alternative ingredients. This lack of information often leads aquafeed manufacturers to extrapolate the nutritive value of ingredients from their chemical composition. Because a simple biochemical analysis and the presence of protein and amino acids in the ingredients does not ensure the level of digestible proteins and amino acids required for particular fish species. It is important to conduct digestibility experiments to identify the digestibility of ingredients and formulate the diet based on the digestible nutrient content, which can reduce feed costs, nutrient pollution (including phosphorus and nitrogen eutrophication emissions), and improve the feed conversion ratio of aquafeeds.
Feed Conversion Ratio (FCR)
The development of sustainable feed using alternative ingredients should be informed by the efficiency of feed with a lower FCR. A common measure of efficiency is the feed conversion ratio (FCR), calculated as the ratio of feed intake to weight gain. It reflects the environmental perfor-
mance of the aquaculture because it provides an indication of the phosphorus and nitrogen waste outputs in the aquatic environment with potential negative consequences of eutrophication, greenhouse gas emissions, loss of biodiversity, and other ecosystem services. Additionally, the contribution of aquacultures to greenhouse gas emission is strongly related to the FCR and the origin of the feed components.
Now it is time to make more sustainable feed formulations for species such as carps, catfishes, tilapia, and marine shrimps. It is important to conduct more research on the LCAs of currently available unconventional feedstuff to better understand the more sustainable future ingredients for aquacultures.
Novel Technology for Improving Ingredients Quality
Improving the overall feed efficiency/feed conversion ratio and digestibility of protein ingredients will help the aquafeed industry meet the global demand for these limited ingredients. New technologies have been developing to process the ingredients that can improve the feed efficiency/feed conversion ratio, digestibility, and protein efficiency.
Extrusion Processing. The novel extrusion technology offers the advantage of making use of a wider variety of ingredients. For example, twin screw extruder technology can be used to process, stabilize, and incorporate ingredients. The extruder has various capacities, along with drying, grinding, and other related equipment to conduct pilot-scale manufacturing tasks.
Use of Exogenous
Enzymes
in Aquafeed. Protease enzymes may stimulate endogenous peptidases by improving protein digestibility and hydrolyzing proteinaceous antinutrients such as lectins, trypsin inhibitors, antigenic proteins, and antinutritional allergenic proteins such as glycinin, β-conglycinin, and kafrin. High-quality proteases or cocktails can be de-
veloped for specific proteins (e.g., the keratin-rich poultry feathers) based on the digestive conditions (e.g., stomach or intestinal pH), which could help enhance dietary protein digestion and utilization.
Use of Additives in Aquafeed to Improve Palatability. The supplementation of taurine with alternative ingredients would enhance the palatability of low fishmeal or fish-free feeds and improve digestion and lipid adsorption. Taurine is a neutral beta-amino acid derived from the metabolism of sulfur containing amino acids. In the past, taurine was not considered an essential nutrient for fish, but recent research showed that it plays a key role in aquaculture nutrition to improve growth feed intake and feed utilization.
Challenges with Adopting and Opportunities to Adopt the New Aquafeeds
The aquafeed industry will use alternative ingredients only if it is at a cost competitive with soy and corn and at a constant quantity of supply. Therefore, researchers and

» 16 FEBRUARY - MARCH 2023 ARTICLE
aquaculture industry stakeholders need a collaborative effort and need to pursue stepwise research to identify a prime alternative that will be productive and profitable while minimizing negative environmental, social, and economic impacts. Towards this end, scientists should be pursuing stepwise research to find a sustainable solution, whether it is a novel ingredient or a combination of these ingredients or a coproduct or byproduct that can partially or fully replace crop proteins in aquafeeds, and to determine how this combination affects fish growth, flesh quality, and economic and environmental performances.
An evaluation of the sustainability of new ingredients is gaining attention. We should acknowledge that the major challenge is generating consistency with the supply of microalgal ingredients to produce large quantities on an industrial scale. Another big challenge is the competitive price of unconventional ingredients with conventional ingredients. Price is the major constraint that will dictate the future course of the
aquafeed sector and industry. Consequently, scaling up is a real block for these novel ingredients.
At this moment, adopting novel ingredients is still challenging and may not be equitable to all producers across the world. There are multiple regulatory, economic, and environmental challenges that accompany switching from conventional aquafeeds to ones based on innovative ingredients, especially for smaller producers and producers in developing countries.
Conclusions and Future Steps
Regarding progress towards the development of novel ingredients, it is imperative to determine the nutritional evaluations of each ingredient, which includes the determination of nutritional value, palatability and feed intake, and digestibility, and requires researchers to conduct nutritional feeding experiments in the lab and feeding/growth trials at commercial farms.
Some ingredients may require additional processing to improve digestibility, the FCR, and reduce the
Improving the overall feed efficiency/feed conversion ratio and digestibility of protein ingredients will help the aquafeed industry meet the global demand for these limited ingredients.

antinutritional factors. The various processing could also increase the opportunities to produce lower-cost protein-rich ingredients and might reduce the overall costs of production. In the final stage of the nutritional evaluation of alternative ingredients, a comprehensive economic analysis is also important to inform decisions about the inclusion of unconventional ingredients into diets that are cost competitive with conventional ingredients.
To fully develop sustainable alternative ingredients, scholars must use systems-based approaches that integrate knowledge and expertise across multiple disciplines including fish nutritionists and aquaculture scientists to conduct on-farm feeding trials with farmers, environmental scientists, technoeconomic and lifecycle practitioners, extension scientists, and economists.
» 17 FEBRUARY - MARCH 2023
This is a summarized version developed by the editorial team of Aquaculture Magazine based on the review article titled “MICROORGANISMS IN FISH FEEDS, TECHNOLOGICAL INNOVATIONS, AND KEY STRATEGIES FOR SUSTAINABLE AQUACULTURE” developed by: PALLAB K. SARKER - Environmental Studies Department, University of California. The original article was published on FEBRUARY, 2023 through Microorganisms. The full version, including tables and figures, can be accessed online through this link: https://doi.org/10.3390/microorganisms11020439.
Marine microalgae commercial production

improves sustainability of global fisheries and aquaculture
Marine microalgae are the natural source of proteins and oils in the marine food web. Here is described a method for saving 30% of the world fish catch by producing fishmeal and fish oil replacement products from marine microalgae.
By: Aquaculture Magazine Editorial Team*
Fishmeal and fish oil are unique nutritional ingredients, produced by rendering ~30% of the wild fish catch. Annual production has been limited since the 1980s, when global fish catch reached maximum sustainable yield, at 5-6 million tons’ fishmeal and 1 million tons’ fish oil.
Demand has been increasing, especially as an essential ingredient in aquafeeds. Fishmeal offers a high-protein (60–65%) ingredient, with a balanced amino acid profile. Fish oil has a high level of n-3 highly unsaturated fatty acids (HUFA), which promote optimal growth and health. Prices of both commodities have more than tripled in the past 10 years. The aquaculture industry is the fastest-growing sector of food production in the world, growing at 8.8% per year from 1980 to 2010.
The question is, where will fishmeal and fish oil come from in the future? The present supply is unsustainable. Replacements have been sought, but no satisfactory replacement products exist. The best alternate sources of protein currently available - soybean protein concentrate, wheat gluten, or corn gluten - still need to be supplemented with
essential amino acids like methionine and lysine. Plant protein meals also contain anti-nutritional components which compromise digestion. Replacements for fish oil are more problematic, as direct sources of n-3 HUFA are not produced in sufficient quantities by terrestrial plants.
The best sources of protein and oil for the diets of marine animals are marine microalgae, the very base of the marine food chain. Marine microalgae have a balanced amino acid profile, and some of them are the natural source of n-3 HUFA. Microalgae would be a commercial replacement for the highest quality fishmeal and fish oil but the cost of production has been considered too high. Here we present a study that builds on recent advancements in large-scale algae productivity.
Methods
The algae production system modeled in this study (Figure 1) is based on the cultivation facility presented by Beal et al. and Huntley et al., but is located in Thailand and modified to include a total lipid extraction using ethanol and hexane. The cultivation facility consists of a hybrid system of photobioreactors (PBR) and race-
» 18
GREENHOUSES AND POND LINERS
way ponds for cultivation of Desmodesmus sp. The facility includes 92 ha of sunlit cultivation area and 114,000 m3 of growth volume. Seawater is supplied from a 50-m pipeline and a gravity-based canal system typical of Thailand aquaculture (requiring 0.9 kJ/L for pumping).
The total capital cost for the facility is $29.3 M. All capital costs were adjusted to Thailand prices using a geographic cost modifier of 0.58 with respect to costs in the U.S. as determined previously by Beal et al. Labor requirements to grow and process the algae are based on Beal et al., but adapted to Thailand labor costs.


Results
Techno-economic Results
The Net Present Value (NPV) of the facility after 30 years of operation was determined to be $26.9 M. This profit represents a 92% return on investment. During the first 10 years of operation, when loan payments and depreciation are applied, the cumulative discounted cash flow increases from $11.7 M to $9.5 M. From year 11–30, annual gross revenue ($10.7 M) exceeds annual costs ($4.1 M) by $6.6 M, resulting in $1.3 M of annual
Prices of both commodities: fish meal and fish oil have more than tripled in the past 10 years.
» 19
tax payments and a steady increase in cumulative discounted cash flow to $26.9 M. The largest contributors to the capital costs ($29.3 M) include pond liner ($8.4 M), pipes ($3.8 M), pumps ($2.8 M), ring dryer ($1.6 M), filter press ($1.2 M), extraction equipment ($1.2 M), and buildings ($1.3 M).
When summing other costs over the entire 30-year facility lifetime, the largest costs include: taxes ($45.9 M), carbon dioxide ($38.6 M), PBR plastic ($15.0 M), labor ($11.1 M), electricity for circulating growth volumes ($10.7 M), heat ($8.6 M), loan interest ($8.2 M), insurance ($7.8 M), maintenance ($7.8 M), ammonia ($7.3 M), and water supply electricity ($6.3 M), for a total of $168 M. Revenues from algae oil (fish oil replacement) and residual algal biomass (fishmeal replacement) over the 30-year facility life are $126 M and $197 M, respectively.
EROI Results
The Energy Return On Investment (EROI) for the facility in this study is 0.69, which indicates that more energy is expended than generated. The largest energy expenditures are associated with carbon dioxide acquisition (44%), heat for extraction and drying (24%), electricity for pond circulation (9%), and electricity for water supply (7%) (Table 1).

As shown in Figure 2, the algal products modeled in this study outperform many other protein sources with respect to EROI. Seafood, in particular, has a very low EROI (0.03), which indicates that replacing fish oil and fishmeal with algal biomass could provide significant primary energy savings. However, the terrestrial feed crops of corn and soybeans have a significantly higher EROI than the algae products in this study. Unlike algae, terrestrial crops do not require external carbon supply or continuous mixing during cultivation, and the drying requirement is much lower than for algal biomass. As a result, the superior areal pro-
ductivity of algae in comparison to terrestrial crops is offset by the carbon and energy demands required for production.
GHG Results
The Life-cycle greenhouse gas (GHG) impact of algal biomass in this production model is 3.96 kg of CO2e per kg of algal biomass (including oil and meal fractions). Similar to the energy impacts, most GHG emissions are associated with upstream impacts for carbon dioxide (56% of total) and heat produced from natural gas (18% of total). The GHG emissions can be compared with soybeans, which can be considered as a reference scenario. The average GHG impact of soybeans sold on the global market, according to ecoinvent 3.2, is 3.90 kg CO2e/ kg soybeans. This is comparable to

the GHG emissions calculated here for microalgae. However, the global number for soybeans is an average of soybean production in several regions and GHG emissions are highly affected by deforestation rates, resulting in a wide range from 0.39 kg CO2e/kg soybean with no deforestation to 5.78 kg CO2e/kg soybean with high deforestation.
The microalgae would then be environmentally competitive only if substituting soybeans produced in regions with high deforestation rates.
Discussion
To replace Thailand’s current fishmeal production with algae meal would require from 98 to 127 such facilities, on a total land area about 10,900 to 14,100 ha. One hundred such facilities (11,100 ha) would pro-
» 20 FEBRUARY - MARCH 2023
GREENHOUSES AND POND LINERS
duce 0.28 million tons yr 1 of protein, comparable to 0.40 million tons yr 1 of fishmeal. This amount of land is currently available in Thailand; as of 2016, more than 750,000 ha were under cultivation for oil palm in Thailand. The 11,100 ha required for 100 algae production facilities represent only 1.5% of the land dedicated to oil palm. Such an industry would require a capitalization of $3.0 billion and would yield annual net income of $0.66 billion on annual sales of $1.0 billion.
On a global scale, replacement of fishmeal by algae meal would need about ten times more capital and land, for a total of $30 billion and 111,000 ha. Granted that the algae facilities are not likely to all be located in Thailand, despite the modest amount of land required, we presume that enough land can be found in comparable environments – tropical locations where the cost of capital and labor are comparable to those in Thailand, or perhaps even more favorable. Global net income of $6.5 billion on sales of $10 billion await players in this new industry, which is poised to grow quickly.

Algae production is a far more sustainable industry than continuing to harvest 30% of the world fish catch for fishmeal and fish oil at everincreasing cost. The release in fishing pressure could have a dramatically favorable effect on marine ecosystems. The fishes that are caught for rendering into fish oil and fishmeal are typically small, primarily herbivorous fish such as anchovies and menhaden. By not fishing for these fish we leave a huge food resource behind that fuels the production of fishes at higher trophic levels, including finfishes like tuna and salmon that are currently limited in supply. This would reverse the trend of fishing down the food web and would go a long way towards restoring sustainable global fisheries.
Conclusion
A viable commercial technology is presented for producing marine microalgae to replace the unsustainable supply of fishmeal and fish oil. In Thailand alone, which produces about 10% of the current world supply, an investment of $3.0 billion on only 11,100 hectares, roughly 1.5%
of the land now dedicated to oil palm production, would yield annual net income of $0.65 billion on sales of $1.0 billion. The global market would be ten times more profitable. If microalgae were used to replace fishmeal and fish oil globally, the effect would be to remove 30% of fishing pressure at the lower end of the food web and would contribute to a restoration of marine ecosystems.
This informative version of the original article is sponsored by:
This is a summarized version developed by the editorial team of Aquaculture Magazine based on the review article titled “MARINE MICROALGAE COMMERCIAL PRODUCTION IMPROVES SUSTAINABILITY OF GLOBAL FISHERIES AND AQUACULTURE” developed by: COLIN
M. BEAL - B&D Engineering and Consulting LLC and Pacific Aquaculture & Coastal Resources Center; LÉDA

N. GERBER - Pacific Aquaculture & Coastal Resources Center; SUPIS THONGROD - Thai Union Feedmill Co., Ltd.; WUTIPORN PHROMKUNTHONG - Prince of Songkla University; VISWANATH KIRON, Nord University - JOE GRANADOS - Pacific Aquaculture & Coastal Resources Center; IAN ARCHIBALD - Pacific Aquaculture & Coastal Resources Center and Cinglas Ltd; CHARLES
H. GREENE - Pacific Aquaculture & Coastal Resources Center and Cornell University; MARK E. HUNTLEYPacific Aquaculture & Coastal Resources Center and Cornell University. The original article was published on OCTUBRE, 2018, through NATURE. The full version, including tables and figures, can be accessed online through this link: DOI:10.1038/s41598-018-33504-w
» 21 FEBRUARY - MARCH 2023
Mexican field trial shows clear potential for hatcheries to improve their bottom line
By: José Virgilio Jiménez Ayala, Geert Rombaut and Eva Werbrouck*
A recent field trial conducted by INVE Aquaculture shows that an optimized feeding protocol can help hatcheries get the most out of their 4-month season thanks to a 27% increase in PL production and a 20% higher profitability.
Due to seasonal temperature changes, Mexican shrimp hatcheries need to produce 70% of the national PL demand between March and June, so grow-out farms can focus their culture on the summer. For the hatcheries, this means achieving high volumes through large production capacity increased stocking density, faster growth, and the implementation of a two-culture phase system. A recent field trial conducted by INVE Aquaculture shows that an optimized feeding protocol can help hatcheries get the most out of their 4-month season thanks to a 27% increase in PL production and a 20% higher profitability.

Average body weight as key performance indicator
In Mexico’s standard two-culture phase system, the first phase covers nauplii stage 4-5 to post-larval stage 6 (PL6), and the second phase covers PL6 to PL12 (harvest stage). Average body weight samples taken upon transfer from phase 1 to 2 indicate that substantial improvement of this important culture parameter is possible.
“Although larval development and growth can be positively impacted by factors such as genetic improvement of breeding lines, stocking density, and water management, optimized nutrition still seems the obvious solution. That is why we set up a trial to investigate if a carefully balanced feeding protocol could add effectiveness to the larval rearing stages, allowing hatcheries to produce more,
faster growing, and stronger postlarvae”, said Alfredo Medina Rodas, Global Technical Expert Shrimp Hatchery at INVE Aquaculture
Hatchery trial with INVE’s ‘Best Balance’ feeding protocol
The objective of the trial in a commercial hatchery in Sonora State, Mexico, was to evaluate the productive and cost-benefit performance
» 22 FEBRUARY - MARCH 2023 ARTICLE
Mexican shrimp hatcheries need to produce 70% of the national PL demand between March and June, so grow-out farms can focus their culture on the summer.
of INVE’s ‘Best Balance’ feeding protocol in comparison with the local standard hatchery protocol. Part of the tanks was fed according to the hatchery’s standard protocol. The other tanks were fed according to INVE’s ‘Best Balance’ protocol. Other aspects of the culture management such as water treatment and microalgae cultivation were kept in line with the hatchery’s standard procedures.
Importance of Artemia
The hatchery standard protocol used different types of feed and brands (liquid diets, microparticles feed, and flakes) as well as additives, multivitamins, and probiotics from different commercial manufacturers. Regular EG type of Artemia cysts were used, and traditionally harvested using a double mesh to separate the nauplii from the empty cysts, and hot water (75°C) for disinfection.
As shown in Table 1, INVE’s ‘Best Balance’ protocol included 68% more Artemia and 28% fewer diets on dry matter basis.

More concretely, the protocol included the following INVE products: 9 EG SEP-Artcysts 225 Knpg, hatched according to the IFU and the nauplii separated from their shells and cysts using INVE’s SEP-Art CysTM 2.0 tool. This equipment consists of 16 magnetized bars that retain the cysts and empty cyst shells, keeping the nauplii in the suspension without damaging or injuring the nauplii (Figure 1) and maintaining the feed quality.

9 FRiPPAK® FRESH diets (#1 CAR, #2 CD, #3 CD) and FRiPPAK® PL+ ULTRA diets (PL+150, PL+300), and health booster diet Sano S-PAK (0/2). FRiPPAK ® FRESH diets contain microencapsulated particles to keep the nutrients from leaching into the water. Appropriate particle size in function of the stage is crucial e.g., for zoea stages the size should be below 50 µm for optimal ingestion.
9 Sanolife® MIC and Sanolife® PRO-W were used as probiotics and Sanocare ® FIT as a water conditioner.
“The Best Balance protocol draws its beneficial effects from a substantial increase in the amount of Artemia used. But the impact on the hatchery team’s workload remains limited thanks to INVE ’s SEP -Art tools, which drastically simplify the Artemia harvesting process”, emphasized José Jaime Muñoz Medina, Sales Manager Mexico.

» 23 FEBRUARY - MARCH 2023
Alfredo Medina Rodas.
Average
Technical results
As shown in Table 2, the observed results at the end of the first larval rearing phase demonstrated a clear impact on growth, biomass reached per tank, and feed conversion rate (FCR). Compared to the standard hatchery protocol, INVE’s ‘Best Balance’ protocol resulted in similar survival, but with higher average PL body weight (+43%), higher tank biomass (+35%) and a 20% more efficient FCR.

Evaluation of growth
Growth was evaluated through daily body weight evaluation from PL3 onwards using the LarvIA application, previous values were estimated according to the trend (Figure 2).
Profitability at the hatchery’s operational level
Post-larvae cultured under INVE’s ‘Best Balance’ protocol reached transferable size in 12 days (1.4 mg/PL3), while it took 15 days under the standard protocol (1.3 mg/PL6). A shorter phase 1 culture period not only

» 24 FEBRUARY - MARCH 2023
body weight samples taken upon transfer from phase 1 to 2 indicate that substantial improvement of this important culture parameter is possible.
ARTICLE
Compared to the standard hatchery protocol, INVE’s ‘Best Balance’ protocol resulted in similar survival, but with higher average PL body weight (+43%), higher tank biomass (+35%) and a 20% more efficient FCR.

brings the opportunity to run more production cycles per season, but also enhances the survival rate. Considering a 4-month season, this implies 8 cycles with the standard protocol versus 10 with INVE’s ‘Best Balance’ protocol. This means a 27% increase in PL production, e.g. from 1 million to 1.27 million PL produced. The consequent additional revenues far outweigh the extra costs linked with increased PL production (nauplii cost, phase 2 feed cost) and the additional feed cost of INVE’s ‘Best Balance’ protocol during phase 1 (Table 3). Table 4 summarizes the economic analysis of the hatchery’s standard protocol versus INVE’s ‘Best Balance’ protocol and concludes on an increased profitability of 20%

Conclusion
9 The use of INVE’s ‘Best Balance’ protocol in phase 1 of the hatchery culture cycle increased PL size and harvestable tank biomass and improved the feed efficiency.
9 The higher inclusion of Artemia was the main driver for increased growth.
9 Increased PL size allows for more cycles per season, and thus a higher seasonal PL production.
9 INVE’s ‘Best Balance’ protocol unlocks the hatchery’s production potential and increases the hatchery’s profitability.
9 ‘Best Balance’ aims to deliver robust post-larvae that maintain their high-quality during growout.
For more information about the Best Balance protocol, please contact the technical support team by sending a request to customer.support@inveaquaculture.com

» 25 FEBRUARY - MARCH 2023
José Virgilio Jiménez Ayala Sales Manager Mexico. Geert Rombaut Product manager Artemia and Live Feed. Eva Werbrouck Product Manager shrimp formulated diets. INVE Aquaculture (A Benchmark Company)
This informative version of the original article is sponsored by: INVE AQUACULTURE.
Note: ‘Best Balance’ is not a fixed protocol, but an approach to shrimp hatchery culture in which the use of high-quality products is adjusted to local culture conditions.
Internet of Things in aquaculture: A review of the challenges and potential solutions based on current and future trends
In aquaculture, it is important to evaluate and address the challenges related to Internet of Things (IoT). Here is a review that categorizes the challenges associated with implementing IoT systems in aquaculture according to the literature and provides some potential solutions based on trends.
 By: Aquaculture Magazine Editorial Team*
By: Aquaculture Magazine Editorial Team*
In aquaculture, keeping water quality at the desired level, providing proper nutrition, promoting breeding, and preventing diseases and predators are the main factors that result in successful farming. Aquaculture pro-
duction enjoyed a growth rate of at least three percent during 2011-2019. This is due to the growing trend of the world population and limited wild aquatic resources. However, there are still many challenges in aquaculture that need to be addressed. Maximiz-
ing the yield via efficient use of resources is one of the main challenges that could be addressed by precision aquaculture. Precision aquaculture tries to achieve its goal, i.e. ensuring profitability, sustainability and protection of the environment, by incor-
» 26 FEBRUARY - MARCH 2023 ARTICLE
Smart aquaculture involves the use of advanced technologies and data-driven approaches to improve the efficiency, sustainability, and productivity of aquaculture operations.
porating different innovative technologies such as Artificial Intelligence (AI) and the Internet of Things (IoT) in aquaculture.
In other words, this type of aquaculture converts traditional experienced based practices to knowledge based with the aid of state-of-the-art technologies. Smart aquaculture, also known as intelligent aquaculture or digital aquaculture, is a concept that involves the use of advanced technologies and data-driven approaches to improve the efficiency, sustainability, and productivity of aquaculture operations. Actuators and sensors are placed in the physical environment so that they can either measure different water parameters or affect the environment in a specific manner. A gateway acts as a transceiver of data between sensor/actuator nodes and other parts of the IoT system with the help of a gateway. IoT devices
are usually connected to a Wireless Sensor Network (WSN) by which all network communication happens. An example of a WSN can be seen in Figure 1, highlighted and tagged in light blue color, by combining sensors, actuators, and a gateway.
This article presents a summary from a paper that introduces a broad categorization of reported challenges in literature and then seeks possible solutions for these challenges.
Challenges of IoT in Aquaculture

Using literature as a guide, were identified two major categories of challenges. The first category (Common challenges) includes general problems that may occur for most IoT systems including aquaculture.
The second category (Specific Challenges) covers specific challenges raised by different aspects of aquaculture, such as scarcity of electricity,
inadequate communication coverage, harsh environment, and inadequate technology.
Common challenges
The permanent contact of sensors with water, which is usually polluted, reduces the accuracy of readings over time. To overcome this issue, the literature either suggests regular maintenance, i.e., cleaning, of the probes or in some cases special mechanism was developed for automatic probe cleaning.
The incorporation of a sensor cleaning mechanism increases the overall cost of any IoT solution. However, it assures accurate reading of the need for manual maintenance. The design of the cleaning system must be in such a way that does not affect sensor readings. In an effort for cleaning sensors, a mechanism was designed that disseminates air
» 27 FEBRUARY - MARCH 2023
bubbles around sensors to prevent dirt on the surface. Such solutions might cause inaccurate readings of dissolved oxygen due to the high concentrations of oxygen molecules around the probe. A self-cleaning mechanism was designed to clean sensor’s probe after every measurement. This was done by designing a special robotic arm that automatically performs the measurement, rinsing the sensor probe. The proposed system submerges the sensor in the protective solution if it is not going to be used for long time.
Specific Challenges
Depending on the species and accessibility of farm, certain challenges occur more frequently in different farming setups. Table 1, lists challenges for implementing IoT in aquaculture systems over two dimensions. Rows are referring to the farm’s accessibility to basic facilities and columns refer to the type of species under culture. A farm with no access to electricity or internet access is considered to be in a rural area.

Whereas farms in urban areas have access to both of these facilities. A farm with basic facilities would face fewer challenges in comparison to a farm that is located in a rural area. Likewise, sensitive species demand higher reliability and quality in design, hardware, and software. Contrary to this, simpler and more economical IoT systems could be designed for species that are less sensitive. Such Categorization resulted in four different scenarios in which any given farm falls in one of them.
There are different challenges related to each scenario that are grouped into three different categories including infrastructure related challenges, data related challenges, and perception related challenges. The higher is the number of challenges, the higher is implementation cost of the IoT system. It is due to the number of challenges that need to be resolved. As it could be seen,
most of the challenges are for the farms with sensitive species that are located in rural area. Resolving the challenges could be done by taking one of the following approaches.
Infrastructure Related Challenges
Access of the farm to the electricity and internet are two main infrastructural issues that can affect the design of IoT systems.
Electricity
The lack of electricity in rural areas or marine aquaculture and the unreliability of electricity in urban area has been recognized as one the challenges that need to be addressed. Most IoT devices are designed in such a way as to operate on low power, meaning that they can operate for a reasonably long time on batteries. Solar panels and photovoltaic batteries have been shown to be a realistic solution that addresses this issue. However, a reliable operation of other hardware equipment using solar energy demand careful design. For example, reliable powering of aerator for fish farm using solar photovoltaic and the battery has shown to be dependent on the size of the pond. It is worth mentioning that, while the incorporation of solar panels and batteries would add to the overall costs of the farm it has shown to be more cost effective than a gasoline-based solution or even electricity for the power grid.
Most of the proposed solutions in the literature are based on online monitoring of water quality. Continuous monitoring of water quality
consumes more power and therefore, optimizing power consumption by reducing sampling periods to as low as possible would result in maximizing the battery life span. Using the current technology IoT nodes could go to sleep mode by which power consumption reduces effectively. Though periodical sampling would reduce the number of readings, most of the time incorporation of the machine learning methods would result in predictions that are comparable with actual reading.
Network
Internet access enables the IoT system to transfer data to the cloud and thus it could be analyzed and monitored from anywhere. Different networking protocols could be used for transceiving data from/to the farm to/from the internet. However, it has to be noted that the long-range networking protocols are designed for low-rate data transfer. As a result, while most of the requirements of IoT aquafarm will be covered, special requirements like transferring video data would not be possible using most of these technologies. Authors asserted that due to the nature of these networks it is impossible to transfer video over them. However, there are other protocols like CoAP that can transfer high-rate data including video.
Recent technological advancements show that globally accessible internet is no more a dream. This technology, i.e. reliable high-speed internet, has been available in some
» 28 FEBRUARY - MARCH 2023
ARTICLE
parts of the world for the past few years and is expected to be expanded to more locations in near future. However, just like any other new technology early adoption of this technology would be costly. Sharing is a potential strategy that can be considered by small farms in rural locations to reduce adoption costs.
In recent years, edge computing has enabled most computations to be performed on-site. Edge computing could increase Quality of Service (QoS), response time, and security. Moreover, when no additional offsite data is required for computing it reduces the dependency of the IoT system on to the cloud. In other words, the implementation IoT system by considering edge computing enables the whole system to act without reliance on cloud resources. Another common problem, more relevant to offshore farms, is known as the cable breakage problem of underwater sensor networks. Optimizing the wireless network and proposing a mixed wireless-wired topology have shown to resolve the problem effectively.
Data Related Challenges
The quality of measured data is very important as the whole purpose of an IoT system is to facilitate datadriven decision making. Many factors affect the quality of data along the
way starting from the source of data to the quality of sensors that is of high importance for collecting high quality data.
Device Error. Different vendors provide different made of the same sensor, suitable for different environments ranging from hobby usage to industrial use. Moreover, different sensors have different qualities that generally will be mentioned in terms of error rate for each sensor. The lower is the error the higher is accuracy (quality). The accuracy of the sensors is in direct relation to their price. There is a direct relationship between the price and the accuracy of a temperature sensor.
Another source of data inaccuracy is related to the fact that some sensors may demand regular maintenance which could be in the form of performing regular procedures recommended by manufacturers or changing consumable parts. For example, pH sensors need to be recalibrated from time to time; most sensors require routine cleaning. This is due to multiple reasons such as biofouling that cause drift in sensor accuracy. A method was proposed for automatic cleaning of the sensor head by air through an air pump. Nevertheless, this method demands energy for powering the air pump and also does not apply to all environments.
Access of the farm to the electricity and internet are two main infrastructural issues that can affect the design of Internet of Things systems.

While sensors with higher prices offer higher accuracy, the chance of receiving erroneous data increases over time. Therefore, the incorporation of the following methods, besides performing maintenance procedures, for correcting the sensor readings has shown to be effective.
- Incorporating the data fusion technique to improve data quality and also reduce the frequency of data transmission over the network and thus saving energy.
- Incorporating anomaly detection and other intelligent algorithms to improve and predict sensor values.
» 29 FEBRUARY - MARCH 2023
The quality of measured data is very important as the whole purpose of an IoT system is to facilitate data-driven decision making.

Resending the same reading multiple times could decrease the chance of data loss. However, different policies could be taken into account to overcome this issue such as interpolation or other statistical methods, utilizing more reliable radio and antenna configuration, or even deployment of an IoT platform on a local server as a solution that removes the need for internet connection.
Perception Related Challenges
According to an empirical study, the general perception of small business farmers was that IoT is not useful in aquaculture. Lack of confrontation of the farmers with successful exemplary farms was found as the main reason for this finding.
In a multi-depth temperature sensor network, 15 marine buoys were placed in different locations in the sea. The proposed system consisted of two software modules namely the accumulation system, and the visualization system. Sensor nodes send the temperature data by emailing them to a mail server. Data of each node then will be stored in the text format in a separate file that will be used later for visualization purposes. Interpolation was used to calculate the temperature for both missing sensor data and the predicting temperature value in the location between sensors.
Network Error. Lossy networks affect the smooth collection of data. Most of the IoT platforms store collected data as time series. Losing data at a different time could affect the overall computation. Packet loss in networks is a well-known topic of research where the transition of data packets fails due to many reasons such as often poor received signal strength indicator (RSSI) values and signal-to-noise ratios (SNR).
Many authors, suggested that policy makers should come up with pilot farms equipped with IoT facilities and show the effectiveness of it to the farmer empirically which may ease the adoption by farmers. The cost of the IoT systems has also been an adoption barrier for small business aquacultures. While incorporating industrial grade sensors should not be missed if possible, it has been shown that it is possible to implement practical and reliable IoT systems using low cost sensors as well.
The economical design of the IoT system could also reduce costs without losing quality. For example, combining the gateway with a node eliminated the need for a specific gateway node and therefore the cheaper system was offered.
Future Trends
Some potential future trends that may help tackling the challenges of IoT for aquaculture are discussed with regards to the type of the challenges categorized as follows:
Common challenges. Development of antifouling methods is an active research field in literature where it’s outcome could be used for sensors in aquaculture. These
methods are more focusing on use of chemical and Nanocomposite technology for reducing accumulation of biofilm on the surface of the sensors and other equipment in direct contact to water.
Specific challenges. The specific challenges are subject to the aquaculture environment and setup, i.e. type of species and location of the farm. Therefore, not all of the IoT
» 30 FEBRUARY - MARCH 2023 ARTICLE
systems in aquaculture are expected to face the related challenges in this category. Nevertheless, advent of energy harvesting and renewable energy technologies such as solar, wind, wave etc. are expected to alleviate some of the challenges related to the energy and electricity of the farm located in rural area. While utilization of floating solar panel and wind turbine are a feasible com -
mon evolving practice, application of newer sources of energy such as hydrogen has also shown promising applicability. Advancement in battery production industry could also affect the challenges in IoT systems for aquaculture. Data fusion and sensor fusion are also active research fields that could be practiced for tackling both network and data errors and increasing accuracy and reliability of data.
Conclusion
The application of IoT is spread out in almost all industries. Aquaculture as a subfield of agriculture is not an exception. While there are many challenges related to the IoT in general, some of the challenges are related to aquaculture. The present article is a review of reported challenges regarding the incorporation of IoT systems in aquaculture. Furthermore, possible solutions that could resolve reported challenges were discussed.
This is a summarized version developed by the editorial team of Aquaculture Magazine based on the review article titled “INTERNET OF THINGS IN AQUACULTURE: A REVIEW OF THE CHALLENGES AND POTENTIAL SOLUTIONS BASED ON CURRENT AND FUTURE TRENDS” developed by: HAJAR RASTEGARI- University Malaysia Terengganu, FARHAD NADI - University Malaysia Terengganu and Institute of Tropical Aquaculture and Fisheries, SU SHIUNG LAM, MHD IKHWANUDDIN AND NOR AZMAN KASAN - University Malaysia Terengganu, ROMI FADILLAH RAHMAT - Universitas Sumatera Utara, WAN ADIBAH WAN MAHARI -University Malaysia Terengganu. The original article was published on MES, AÑO, through SMART AGRICULTURAL TECHNOLOGY. The full version, including tables and figures, can be accessed online through this link: https://doi.org/10.1016/j.atech.2023.100187

» 31 FEBRUARY - MARCH 2023
Sustainable Aquaculture Ecosystem Solutions in e-Commerce Business
 By: Aquaculture Magazine Editorial Team*
By: Aquaculture Magazine Editorial Team*
One of the opportunities to increase the amount of food production for food sufficiency is through aquaculture. Advances in technology and telecommunications support the development of online-based businesses such as e-commerce. By using e-commerce, manufacturers can market various products or services worldwide. Here is a study that describes aquaculture solutions in the e-commerce business in Indonesia.
The food problem is a comprehensive problem that threatens all humanity. After the COVID-19 pandemic came along, 811 million experienced hunger, and it is estimated that by 2030 this number will increase. The increasing growth due to food conditions in Indonesia causes the supply conditions of foodstuffs to be smaller than the demand. In addition, the community is considered too dependent on agricultural products rather than aquaculture.
The pandemic condition in early 2020 caused a prolonged impact on food security. The issue of environmentally friendly and sustainable business is essential in the economy.
As a maritime archipelagic country, Indonesia has a large water area, so the water resources are relatively large. Based on this, several companies have emerged that are engaged and conservancy to become solutions to increase production and food security in the water sector. One of these companies is eFishery, a social entrepreneur startup that has successfully reduced water pollution’s impact on fish feeding patterns. eFishery helps fish farmers to organize fish feeding schedules and suppress fish deaths due to poisoning. The company is the first aquatech field in Asia, supported by technological advances in aquaculture to facilitate fish farming, access to capital, and easier sales of harvests.
Indonesia big contributor to the world’s fish farming production
Indonesia is the second contributor to the world’s many fish farming productions. However, this higher contribution level must be balanced with the growth of abilities and knowledge. Besides the limited growth of fish farmers’ ability and knowledge of technology, the climate is also one of the major influences. Climate change is self-evident in the form of rising water temperatures, changes in rainfall and water availability, and increasing the frequency and intensity of storms. All of this has an impact on fisheries production and fish biodiversity.
Currently, aquaculture development shows that rural areas’ characteristics are filled with cultivators on
» 32 FEBRUARY - MARCH 2023 ARTICLE
a small business scale. These cultivators still use conventional technology. It makes it challenging to increase the productivity of fish farming because their accessibility is still not affordable for capital, technology, information, and markets. Aquaculture itself plays a vital role in fish production in the world, where overall, aquaculture contributed as much as 44.1% of the total fish farming production in the world in 2014. This percentage is constantly growing every year. Countries in Asia have contributed 88.91%, and Indonesia ranks second with 5.77% of the world’s many fish farming products. However, this higher contribution level must be balanced with the growth of abilities and knowledge. Aquaculture has been the fastest way to obtain
the fastest source of animal protein food for more than half a century (an average growth rate of 8.1% per year since 1961), with total world production in 2007 reported as 65.2 million tons worth Rp 94,500,000,000. More than 91.1% of total global production is produced in Asia, with China alone producing 63.2% of the global total producing aquaculture fisheries.
In 2021 per capita fish consumption of the world’s population will reach 19.6 kg per year. Although marine fish currently supply more fish consumption, in 2018, freshwater fish production has rapidly progressed compared to the production of capture fisheries. It is because the production of capture fisheries will decrease due to overfishing, making it more difficult for marine
eFishery is a social entrepreneur startup that has successfully reduced water pollution’s impact on fish feeding patterns. It helps fish farmers to organize fish feeding schedules and suppress fish deaths due to poisoning.
fish to be obtained. Even if there is no change in the production model, researchers predict that by 2048 there will be no more marine fish to catch. For this reason, it is necessary to increase the production of freshwater fish farming as a substitute for marine fish so that marine life has the opportunity to breed. However, aquaculture development is not as rapid as the development of agriculture because the food content in lakes, rivers, and seas is so abundant that it is considered unimportant to learn how to cultivate it. In addition, several factors can hinder aquaculture development, including the business and administrative environment and structural regulations that create constraints rather than support further aquaculture development.

» 33 FEBRUARY - MARCH 2023
eFishery provides solutions
One is the existence of a budikdamber system that can overcome the problem of land limitations and decreased quantity and water quality in urban areas. Based on this, eFishery offers automatic fish feed tools that are directly connected to the internet. So that work is more efficient and effective, production of suitable feed for fish types, providing advice for farmers on how to understand the fish feed that should be given, and how to cultivate fish in cities with less water quality. eFishery has a mission as a company that grows a sustainable aquaculture ecosystem following sustainable development goals.
After the Covid-19 pandemic came at the beginning of 2020 has drastically changed lifestyles, including business activities in almost all humanity worldwide, unlike in Indonesia. The habit of wearing masks when going outside, diligently washing hands to maintaining physical distancing to avoid transmission of the spread of the Covid-19 virus. Even before the pandemic came, many small and medium-sized businesses faced the challenges of an increasingly competitive market with increasingly fierce competition because of the industrial revolution 4.0 that was delivered earlier, so the arrival
of Covid-19 has caused conditions to get worse in uncertainty.
However, eFishery can still survive even in such conditions because it uses a digital platform that suits these conditions. Sustainable aquaculture ecosystems have a longer-term concept, namely that there must be equal access and opportunities for future generations. The contribution of aquaculture can be helped by advances in the field of technology today. The technologybased business sector has the potential to maintain food security by building a systematic value chain. An integrated system can produce a sustainable ecosystem based on technology to strengthen global food security in the future.
Many ideas have emerged in the community as technology in this 4.0 era. Business people are asked to be more creative to survive in various conditions. In addition to the rapid growth of technology, the level of information has also experienced significant growth. Advance in the field of technology and information support the emergence of the development of online-based businesses such as e-commerce. e-Commerce gives new ideas to the trading system in technological advances. This technology makes it easier for users to reach a
broader market with a variety of information that is easy to access effectively and efficiently, especially for locations that are difficult to reach through the market to sell aquatic products.

eFishery, as an aquatech company, can provide this through an application with a method of feeding catfish that is scientifically regulated in time and quantity via smartphones. In research conducted by it was shown that the participation of fish cultivators in groups was at an apparent degree of participation with a high frequency of participation. The level of cultivator participation is already at the decisionmaking stage and acts together with the type of functional participation. Based on the above, here we present an exploratory study that aims to describe aquaculture solutions in the ecommerce business in Indonesia. The object of the research is eFishery as the first company in Asia to use the aquatech system to maintain food security in Indonesia in particular and globally in general so that sustainable development goals can be achieved.
Research Methods
The method is a prospective explorative qualitative method, which according to Sugiyono (2019) is often called a “naturalistic research method”
» 34 FEBRUARY - MARCH 2023 ARTICLE
because the research is carried out under natural conditions. The technique used is the collection of secondary data in the form of observations and data from various journals, books, and websites that support this research to provide an overview of the assessment and provide solutions to existing problems based on the results of the evaluation. According to Miles and Huberman in (Sugiyono, 2019) suggests that activities in qualitative data analysis are carried out interactively and continue continuously until complete, so that the data is saturated. Activities in data analysis are data reduction, data presentation, and drawing conclusions or verifying results.
Results and Discussion
The primary mission of eFishery is to create a socially entrepreneurial and sustainable startup. Environmental and social issues a business affects are not new; experts have discussed this for many years. Global trends improve environmental and social performance (Yudawisastra, 2022). eFishery develops an aquaculture system with a mission to address the issue of hunger through the fisheries sector. It is not an easy thing for this achievement.
The existing challenges prompted eFishery to create systematic solutions to facilitate every step of the cultivation process. The eFishery products and services now available fully support the fishing business. eFishery’s products and services exist to build an ecosystem where fish and shrimp farmers can increase productivity while creating a sustainable environment. eFishery is a company engaged in producing fish feeding equipment automatically employing scheduled feeding with the proper dosage and recording each feeding in real-time. This robotic fish feed technology can make it easier for business people in the field of fisheries, both on a home and large scale. So, eFishery provides a desirable and valuable value proposition for its customers.
As the world begins to recover from the Covid-19 pandemic, eFish-
ery continues to support farmers and fish farmers. Over the past eight years, from developing feeders to having a headquarters filled with hundreds of talented eFisheria. eFishery has built more than 100 eFishery points in every corner of Indonesia to provide better assistance to fish and shrimp farmers. The Figure 1, describes the transformation of eFishery to achieve the goal of overcoming food catalysis in order to achieve sustainable development goals.

Digital applications for supporting business
Industrial Revolution 4.0 is one of the implementations of high-tech improvements in the manufacturing sector in the face of competition. The rapid development of technology makes it easier for humans to work and improve production efficiency in various fields such as cultivation, telecommunications, and other industry.
Community empowerment is required to implement an eFishery digitization system due to the Industrial Revolution 4.0. The advantage of eFishery is that it can feed fish automatically according to the chosen dosage and time, and farmers can monitor pond water quality through the eFishery website (Figure 2). Since its establishment in 2013, there has never been an assessment of the usability or usefulness of the eFishery website. It is not known whether the extent to which this website is following what the community needs. As a startup company with a sustainable concept, eFishery is very good at managing websites so people can easily access them. On the homepage, everybody can see the vision and mission of the company, its products, and the ease of joining as part of the sustainability program. The public has unlimited access to location, direct messages, and social media. The products offered by this company are so-
» 35 FEBRUARY - MARCH 2023
The contribution of aquaculture can be helped by advances in the field of technology today. The technology-based business sector has the potential to maintain food security by building a systematic value chain
lutions for cultivators and consumers. One of the sustainable goals of eFishery is to financially support farmers through financing programs, create technologies to improve feed efficiency, accompany a variety of services to boost productivity, and channel crops for sustainable cultivation.
Solutions for fish farmers
The app allows automatic fish feed givers that can be controlled through a smartphone. With Fish eFishery Feeder, users can easily set a feeding schedule with a feed dose that suits the user needs. Every feed issued by eFishery Feeder is recorded automatically so that fish farmers can continue to monitor feed expenditure every day without having to record it manually. eFishery offers the convenience of providing fish feed anytime and anywhere accurately and recorded. Regular and maximally absorbed eFishery feeding will prevent the pond from the danger of overfeeding. Applications for fish breeders consist of eFisheryKu, eFisheryFeeder Fish, Kabayan, eFisheyeed, and Lapak Ikan.
Solution for shrimp farmers
This application is used to increase productivity, maintain pond water quality, prevent outbreaks, and recommend a data-based pond management system, to support the ponds of shrimp farmers.
Solution for Buyers and Consumers
This application ensures buyers can access the best quality fish and shrimp products that can be enjoyed throughout the country with farmers’ crops living, fresh, and frozen form.
Solution for Sustainable
eFishery is committed to sustainability. The application was created specifically to access to capital support services for Indonesian Fish Farmers, providing aquaculture needs with a due payment.


Discussion
eFishery products and services exist to build an ecosystem where fish and shrimp farmers can increase productivity while creating a sustainable environment. eFishery is a company engaged in the production of automatic fish feed equipment using a feeding schedule with the right dosage and real-time recording of each feeding. So, eFishery provides a desirable and valuable value proposition for its customers. As the world begins to recover from the COV-
» 36 FEBRUARY - MARCH 2023 ARTICLE
ID-19 pandemic, eFishery continues to support fish farmers and cultivators.
Over the last eight years, from developing feeders to having a head office filled with hundreds of talented eFisheries Community empowerment is needed to implement an eFishery digitalization system due to the Industrial Revolution 4.0. The advantage of eFishery is that it can feed fish automatically according to the dose and time chosen, and farmers can monitor pond water quality through the eFishery website. This application is used to increase productivity, maintain pond water quality, prevent outbreaks, and recommend a data-based pond management system to support
pond farmers. So it can be said that eFishery can find sustainable solutions and survive in the ecommerce business. Digitalization changes everything about fish, shrimp farming with its uses, automatic fish feed, pond water quality monitoring, and the way consumers get accurate information about the company’s market products.
Conclusion
Based on the description and discussion above, it can be concluded that eFishery can find sustainable solutions and stay in the e-commerce business. Digitalization changes everything about fish, shrimp farming with its uses, automatic fish feed, monitoring pond water quality, and
eFishery’s products and services exist to build an ecosystem where fish and shrimp farmers can increase productivity while creating a sustainable environment.

consumers getting accurate information about the company’s market products. This digital-based sales system is expected to make it easier for employees to check product availability so that the sales process runs without a hitch. Buyers will benefit because there is no indent or pre-order process. The application provided by eFishery makes it easier for farmers and customers because it can be accessed from anywhere without being constrained by space or time.
This is a summarized version developed by the editorial team of Aquaculture Magazine based on the review article titled “SUSTAINABLE AQUACULTURE ECOSYSTEM SOLUTIONS IN E-COMMERCE BUSINESS” developed by: AMNILA HANISAH RIFAINY, JOVITO BENHART, RAMADHAN MOSTAR and RIZKIAN MAULANA - Muhammadiyah University. The original article was published, including tables and figures, on JANUARY 2023, through Jurnal ILMIAH AKUNTANSI DAN KEUANGAN. The full version can be accessed online through this link: https://journal.ikopin.ac.id/index.php/fairvalue.

» 37 FEBRUARY - MARCH 2023
The life of RAS…
It’s been a while since I’ve been able to write. But here we go! Based on my last several months, I thought it might be a good thing to do a general overview of the nuances of RAS (Recirculating Aquaculture Systems).
 By: Amy Stone*
By: Amy Stone*
It’s been a while since I’ve been able to write. But here we go! Based on my last several months, I thought it might be a good thing to do a general overview of the nuances of RAS (Recirculating Aquaculture Systems). Not because I think it is anything earth shattering but more because I think we get so focused that we often overlook things that seem minor but are ultimately very important to the success of a facility.
Key things to consider.
When deciding to either enter the RAS world or modify existing systems, it is important to consider several things. Here’s the caveat: to be clear, this article is not exhaustive nor am I willing to make the statement that it includes everything. Now that we have dispensed with that, these are the items that consistently crop up during discussions with colleagues and customers.
First and foremost, it doesn’t matter how much or how little you spend if at the end of the specified timeframe, you have not made a profit. The timeframe to profit varies greatly based on the animal that is being raised in the system. For instance, tilapia has a shorter growth period than sturgeon. It also depends on the funding sources and ultimately your business plan.
Capital Expenses vs. Operating Expenses
The ratio of capital vs. operational is often reliant on the cost of labor. In many cases, focusing on earmarking money to spend on the capital side of the equation will allow a sustained savings on the operational side. Meaning, the more sophisticated the system, the less labor it requires and
the longer the equipment will last before replacement. There is a point of no return as well as the consideration of whether the work force and local infrastructure can maintain the more automated systems.
In all cases, your return on investment should be a major factor in deciding how to proceed. How long will it take to recover the expenses of
» 38 FEBRUARY - MARCH 2023
TECHNICAL GURU
owning and operating the equipment?
In some cases, capital expenses drive the entire project with less thought given to the operational expenses as those can supposedly be manipulated later.
Here is an example. When making a pump selection, there are a multitude of options. From the more expensive and more energy efficient composite pumps to the less expensive and less energy efficient plastic or cast iron pumps.. Plastic and castiron are often less expensive than reinforced fiberglass or composite materials. However, the FRP and composite materials have a longer lifetime than straight plastic and don’t erode like cast iron. Electricity is one of the biggest expenses in a RAS system and anytime a more efficient filtration piece can be used, the better.

But does it work?
It’s easy to make things look good on paper. But does it work? That has to be something that is explored thor-
oughly. Does the engineer, designer or new farm manager actually have experience working with your animal. As much as we all think we can do anything, we really can’t. I will likely upset some with this comment, BUT a warmwater marine specialist has little to no business trying to design a cool freshwater system and vice versa. The two are really only alike in that they both have water.
I honestly can’t stress this enough. There are experts for everything but no one person is an expert at everything. Please, if you do nothing else, research your experts, consultants, designers, engineers and make sure they are experienced at the applications your facility will need to be successful. If there is no one on your team that has experience with a similar species, you need to keep looking. Please don’t be fooled by a fancy CV.
Now that I have aggravated a bunch of people, please know that after close to 30 years of working in this industry as a farmer, a techni-
I will likely upset some with this comment, BUT a warmwater marine specialist has little to no business trying to design a cool freshwater system and vice versa. The two are really only alike in that they both have water.
» 39 FEBRUARY - MARCH 2023
That minute when your ego surpasses your knowledge, will be the minute that everything falls apart. We’ve all seen it. We’ve all heard it. In many cases, we’ve
cal support person at Aquatic EcoSystems and now a business owner, I wish only the best successes of those out there willing to stick their neck out and start a farm. There is nothing easy about it. And when the team isn’t as robust as it should be, dreams and livelihoods can be shattered.

Skills, skills, skills…
A facility can have the most high-tech equipment known to the industry and still fail. Each facility should be unique in its design and include consideration on the skills of the local workforce. If the people running the system are unwilling or unable to learn how to work with it properly, it will still fail. As the owner/manager of a facility, you can spend an enormous amount of time and money training staff. It is also incredibly difficult to hire trained staff. In many cases, facilities are starting from scratch. And while that can be a very good thing, it can also present difficulties. Take the time to train the staff and set expectations for success.
It’s almost as important to have employees committed to success as it is to have a robust business plan/ facility design. If a facility is lucky enough to have the trifecta of a great
workforce, a great facility and a great business plan, the sky will be the limit. This is almost impossible to achieve. However, it should always be the goal.
Keep in mind, your ego and preconceived notion of your own knowledge may just be the downfall of the entire project. It is critical that you question yourself as much as or even more than you question your team. It’s easy to delude ourselves with thoughts that we really know what we’re doing all the time. I have said it a million times, if I’ve said it at all. That minute when your ego surpasses your knowledge, will be the minute that everything falls apart. We’ve all seen it. We’ve all heard it. In many cases, we’ve all lived it.
There is no shame in admitting you do not know everything. In fact, it is better to surround yourself with those who know more about the things you don’t so that you can always have a good set of checks and balances. If you sit back and watch a room, or listen to those around you, most often it’s the humble people who are winning. And even more likely, you never knew they were as successful as they are because, they aren’t making a big deal about it.
» 40 FEBRUARY - MARCH 2023 TECHNICAL GURU
all lived it.
It’s also important to listen to your team. It seems so mundane to write that we need to listen. Isn’t that in every management book, every self-help book and really every time we turn around, we’re told to listen? However, I can’t tell you how many times I’ve sat in a meeting with clients who are not actually listening to
employees or teammates who actually know how to solve the problem.
The take home…
Keep reviewing everything as often as possible with the most critical eye you can muster. Make sure to surround yourself with people who are willing to tell you when you are
I will likely upset some with this comment, BUT a warmwater marine specialist has little to no business trying to design a cool freshwater system and vice versa. The two are really only alike in that they both have water.

wrong but also when you are correct. Dig deep and make sure people aren’t selling you a bill of goods. The more thorough you are on the front end, the less likely you are to be bamboozled.
Throughout my entire career, all I have wished for is that aquaculture be successful both in the United States and abroad. I know this is not my typical article subject, but I feel that it is important that we pull the curtain back on the things that are really holding back our industry. Food security and availability should be our number one priority and I firmly believe successful aquaculture is a huge parts of making that happen.

» 41 FEBRUARY - MARCH 2023
Amy Riedel Stone is President and Owner at Aquatic Equipment and Design, Inc. She was formerly a Manager at Pentair Aquatic Eco-Systems, and she studied Agriculture at Purdue University. She can be reached at amy@aquaticed.com
Flying with our feet on the ground... toward SMART aquaculture
By: Antonio Garza de Yta, Ph.D.* Vicepresident. CIDEEA / Senior Fisheries & Aquaculture Advisor, AWJ Innovation.
Sixty years ago, the contribution of aquaculture to the production of fish and seafood for human consumption was about 4%; last year (2022) it was an estimated 56%. This accel -
The very rapid growth of aquaculture is not only because it is the most sustainable form of animal protein production on the planet, but because there have been very significant technological advances that have enabled it... but what’s next? Where do we go from here? How far can we trust the technology?

erated growth is not only due to the fact that it is the most sustainable form of animal protein production on the planet. It is also due to the fact that there have been very significant technological advances that
have made this development possible. Technology has transformed and redirected aquaculture, from aeration and formulated feed, to genetic improvement programs, water quality monitoring systems and vac -
» 42 FEBRUARY - MARCH 2023
CARPE DIEM
cines, to automation and the use of artificial intelligence.

Previously, aquaculture was a big black box, where we planted organisms, fed them, asked the midichlorians to grow fast and we did not have diseases, and we harvested without really knowing what was really going on. Little by little we have started to make that box transparent, today we have a translucent box through technological tools that allow us to see what is happening inside our culture systems, analyzing how much and when our organisms are feeding, interrelating this information to the genetic line we use and an important amount of physicochemical parameters of the water, which allows us to use the resources much better and to be more efficient every day. Today, precision aquaculture is the present, but what is next? Where are we going? How far can we rely on technology? There is no doubt that technological advances
are fundamental to the development of aquaculture, but equally important are the people who understand the principles behind them. The combination of technology and professionalization of the industry will save investors from major headaches and losses in the millions.

I know I’m going to touch on very sensitive issues. But aquaculture cannot be done at any cost, even if the markets are there. The carbon footprint is a concept that we must understand and take full responsibility for... Well, only if we want our planet to exist for our grandchildren. The “innovative” ideas of producing organisms completely outside of their environment, in places where energy use is very high, is very unsustainable. It can only be done in places where markets are willing to pay a significant premium for a product they could well get at much lower cost and environmental impact. Many people have dedicated themselves to selling aquaculture projects, not aquaculture, selling technologies that seem idyllic but are in fact a recipe for disaster. Maybe some of these technologies will be part of the tools of the future and may be interesting for a venture fund, but in the case of dealing with an investment fund or with the wealth of small or medium investors, it is a real crime and this fact damaged the reputation of aquaculture, especially because it was intended to massify something that is still in the testing phase and not ready for people with very deep pockets.
The future of aquaculture is ‘zero aquaculture’, with no carbon footprint or negative footprint, making effective use of all waste and co-products. Aquaculture must be designed to solve tomorrow’s problems, not only in relation to renewable energy, recycling and innovative ideas, but also in relation to the creation of arable land and linked to other economic activities
such as tourism. Let’s not forget that the goal is not technology. The goal is to produce food in the most efficient way possible, using as many technological tools as possible, but without being deceived by false promises. It is true that we must try to fly very high, but without losing our feet on the ground.
» 43 FEBRUARY - MARCH 2023
The carbon footprint is a concept that we must understand and be fully responsible for... well, only if we want our planet to exist for our grandchildren.
WAS President 2021 - 2022. Antonio Garza de Yta, President, Aquaculture without Frontiers (AwF), a renowned international aquaculture professional, who holds a Masters degree and a Ph.D. in Aquaculture from the University of Auburn, USA. He is an aquaculture expert, FAO frequent consultant, as well as a specialist in strategic planning. Ex-director of Extension and International Training for the University of Auburn and creator of the Certification for Aquaculture Professionals in that academic institution.
What is the biggest disease issue facing shrimp farming today? AHPNS?
The global shrimp farming industry faces many challenges. It is widely agreed that disease is the most serious of these. It is imperative that farmers learn how to do everything possible to reduce stress and ensure the highest possible levels of biosecurity.
By: Ph.D. Stephen G. Newman*
The global shrimp farming industry faces many challenges. It is widely agreed that disease is the most serious of these. Many diseases occur with regularity and the impact on overall productivity is large. New pathogens appear with dismal regularity. Unfortunately, the very nature of shrimp farming ensures that this will continue to be the case. There are literally hundreds if not more uncharacterized viruses, bacteria, and fungi that are present in production environments. Given the right conditions any number of these could become obligate pathogens. This is why it is imperative that farmers learn how to do everything possible to reduce stress and ensure the highest possible levels of biosecurity. Those farmers without the resources to do this properly pose a risk to everybody else.
Vibrio parahaemolyticus (VP) is water borne pathogen that causes diarrhea in humans when it is consumed in raw seafood including shrimp. It can also cause a rapidly developing fulminating septicemia from minor wounds causing death in 24 hours

» 44 FEBRUARY - MARCH 2023
THE GOOD, THE BAD
AND THE UGLY
even in healthy individuals. Its primary virulence factors for humans are hemolysis (proteins that lyse red blood cells). It is ubiquitous in marine environments and increasing in prevalence in a warming planet. There are over 150 species of vibrios with new species being classified regularly. Of these there are many strains (different phenotypes with enough genetic overlap for them to be considered the same species). Most are not pathogenic although a number can be found in dead and dying shrimp where some presume that they are the cause of the issue. Vibrios are critical in the recycling of chitin which explains their affinity for animals such as shrimp whose chitinous exoskeleton is shed constantly as shrimp grow. Strains of VP can be found in dead and dying shrimp, often as secondary pathogens. That is, they may not be the primary cause for mortality, but they infect weak animals, and the vibrios contribute to the mortality. However, in the last decade strains have appeared that have been the primary (i.e., they are obligate pathogens) cause of massive mortalities in farmed shrimp.
Plasmids are circular extrachromosomal pieces of DNA that can encode for many different traits. Among these are virulence factors and antibiotic resistance. One example is found in salmon pathogenic strains of Vibrio anguillarum (some strains have also been implicated in primary disease in shrimp) where the presence of a plasmid that encodes for genes that produce outer membranes that allow the host to sequester iron, an obligate growth factor, is responsible for virulence. If the plasmid is cured the strains are not virulent.
The strains of VP associated with acute mortality in shrimp have been found to harbor plasmids (copy’s range in number from a few to many) that encode for an unusual pair of toxins that disrupt membrane integrity in the hepatopancreatic (HP) tubules, affecting the ability of the animals to gain nutrition and to grow. It also makes them much more susceptible to secondary infections. Animals that are exposed to high levels of the toxins typically appear sluggish; have reduced appetites and empty guts with the HP appearing pale or white.

The disease was first reported in China in 2009 and spread rapidly throughout SE Asia. The first appearance of what is now known as Acute Hepatopancreatic Necrosis Disease (AHPND) or syndrome (AHPNS) manifested itself as what was coined early mortality syndrome (EMS). Massive numbers of animals died within the first month or so of stocking. It is more than likely present today in almost every country that farms shrimp. It spread into the Americas in 2013 and moved into South America and the US. Initially the focus was on strains of VP as being the sole source of the disease. Subsequently it has been determined that this plasmid has been found in several other species of vibrios and even in a few non-vibrios.
These toxins are known as PirA and PirB. They are structurally similar to toxins produced by several bacteria which impact insects, including Photorhabdus and Xenorhabdus sp among others, although it is not clear where they originated and how they ended up in marine vibrios. Historically, this plasmid was found in a strain of Vibrio campbellii in a culture collection that preceded the first reported incidence
» 45 FEBRUARY - MARCH 2023
of the disease. Likely vibrios containing the toxins have been around for a while (there are also reports of similar pathologies seen decades ago) and something changed that allowed them it to proliferate in the manner that they have. There are at least three possible reasons aside from changes in the strains themselves.
a. The misguided culture of bacteria (probiotics) on pond sides without quality control. Vibrios are ubiquitous. Shrimp farming areas will have vibrios in the sediments, the water and even the air. The toxin containing strains grow rapidly and a mixture of pond water with added nutrients such as molasses contains all that they need to thrive. Thrive they do, easily out growing any bacteria that are added by the farmer. Bacillus spores take time to germinate during which the vibrios proliferate.
b. The excessive use of chlorine. Using chlorine to “kill” off the microbiome leaves a depleted microbiome that is readily colonized by rapidly growing vibrios including the strains that cause AHPNS. These vibrios have traits besides rapid growth that allow them to prevent other bacteria from growing.
c. A failure to appreciate the nature of the disease process. This disease is a toxicities. The toxins and not the presence of the specific bacteria cause the tissue damage. The bacteria don’t have to be present for the toxin to be present although they are the source of the toxins being secreted into the environment. Opportunistic bacteria take advantage of weakened stressed animals and cause secondary infections that kill the animals.
Studies have determined there are many variants of the strains that carry the plasmids. This is not uncommon. It is the nature of plasmids. Some strains carry one copy of the genes encoding the toxins while others may carry many. Some produce no toxins, and some produce variable levels of either or both of them. Since vibrios can be VBNC (viable but non cultivable) not finding the bacteria does not mean that it is not present.
When the toxins are present, they, without the bacteria being present, can damage the HP. There is evidence that suggests that many shrimp can be affected, weakened, and show signs of secondary disease processes after even a low-level toxin exposure. In many hatcheries, there is the distinct possibility that the toxins are present at low levels, high enough to cause pathology, but

» 46 FEBRUARY - MARCH 2023
THE GOOD, THE BAD AND THE UGLY
Likely vibrios containing the toxins have been around for a while.
not high enough to cause mortality. This is a result of efforts to control the vibrio without understanding that the toxins are how the shrimp are affected.
A culprit VP strain (or other vibrio that carries the plasmid) cannot always be found using traditional approaches such as PCR, RT PCR, antibody-based tests, isolation on media, etc. because it is sequestered in some part of the ecosystem that is not being sampled or it is present at low levels. Biofilms are important for many microbes to protect them and serve as the site of quorum sensing. VP and many other vibrios (and non-vibrios) do form biofilms. There is no absolute relationship between the number of bacteria present and the toxin load. A strain could
be present that produces huge quantities of the toxins but is not present at very high numbers. It is prudent when testing for the presence of the bacteria that samples are enriched. This entails growing samples up in broth for 12 to 18 hours and then seeing if VP is present. Also avoid the use of chlorine and the addition of home brewed batches of probiotics. PRO4000x, the first tableted bacterial product for shrimp farming, should be used instead.
There are currently no commercial tools available to determine if the toxin is present, although the technology does exist, and test strips have been developed and evaluated. Getting rid of this vibrio is not easy and the aim should be to minimize it and provide a production environment that is harder for it to thrive in. Avoid the use of outdoors cultures, whether algae, artemia or probiotic bacteria. Use ecofriendly probiotics such as PRO4000x and bacteriophages that are specific for VP (although they likely cannot differentiate harmless strains from those that carry the plasmid with active genes). PCR, while extremely sensitive, does have detection limits. Enrichment should be used for validation that these protocols have been effective in eliminating the culprit vibrios. Keeping it out of the hatchery and nursery tanks/ponds is essential to avoid low levels of damage to the HP, which can lead to increased sensitivity to a variety of pathogens.
Limiting the impact of stress is the biggest challenge facing shrimp farmers. Minimizing stress on the animals is critical for ensuring that susceptibility to disease is not increased, whether it be from obligate pathogens such as viruses, examples of which are WSSV and IMNV (there are many others) and fungi, the foremost example of which is Enterocytozoan hepatopenaei , the etiologic agent of EHP or any number
of other pathogens. Until farmers understand that stress is not an acceptable component of a sustainable production model and ensure that every step is taken to minimize both the presence and impact of stress, disease will continue to be a challenge. AHPNS appears to have moderated in the sense that we are not seeing the large mortality in early stocking that was characteristic of the disease when it first became widespread. Overall toxin loads may be less, but they are not gone. Animals will develop tolerance and eventually even resistance to these toxins. Even with this, pushing productivity beyond the carrying capacity of the production environment will continue to result in animal health challenges.
on microbial technologies and biosecurity issues. sgnewm@aqua-in-tech.com
www.aqua-in-tech.com
www.bioremediationaquaculture.com
www.sustainablegreenaquaculture.com

» 47 FEBRUARY - MARCH 2023
Limiting the impact of stress is the biggest challenge facing shrimp farmers.
Stephen G. Newman has a bachelor’s degree from the University of Maryland in Conservation and Resource Management (ecology) and a Ph.D. from the University of Miami, in Marine Microbiology. He has over 40 years of experience working within a range of topics and approaches on aquaculture such as water quality, animal health, biosecurity with special focus on shrimp and salmonids. He founded Aquaintech in 1996 and continues to be CEO of this company to the present day. It is heavily focused on providing consulting services around the world
One step at a time
By: The Fishmonger*
As individual retailers you may feel that there is little you can do that will impact the global seafood world but, honestly, that could not further from the truth.

As individual retailers you may feel that there is little you can do that will impact the global seafood world but, honestly, that could not further from the truth. Sure, if you just sit back and do nothing and you will be right, but The Fishmonger wants to highlight some issues for you to engage and maybe if you followed up on these ideas you might see how you can add value to the industry.
Here is a great example about Henty, a small town in southwestern New South Wales, Australia close to the boundaries of the Southwest Slopes and the Riverina districts, almost midway between the regional cities of Albury and Wagga Wagga. At the 2006 census, Henty had a population of 863 people. In rough terms it is about 5 hours´ drive to either Sydney or Melbourne.
When graphic designer and mother of three, Izumi Hooper first
moved to Henty five years ago, she was the first and only Japanese national in town. She was warmly welcomed by the local population and settled in well, but she soon discovered that the people of Henty were not very familiar with the traditional Japanese dish of sushi - unlike in most major cities of Australia today.
Izumi was invited to the local Bush Fire Brigade’s Christmas party, so she decided to take a plate of sushi rolls, despite advice by her Australian husband that “no one will eat it”. Basically, he was right except that one lady, the owner of the only café in Henty, thought that Izu’s sushi was the most exotic dish on the table and wanted to add it to her café menu.
From there, began Izumi’s journey to spread the culture of sushi in Henty, providing it for the cafe’s menu. She learned that encouraging the rural community to try something new was not as easy as she had
hoped. Rolls and rolls of sushi went to waste, and Izumi often wondered if it was worth it after all but she continued her quest nevertheless.
Izumi was reported as saying “Persistence was the key. Gradually, people came back for more, and the word spread. Now customers, some who have never before eaten sushi, order a week ahead!”
Importantly the children of Henty loved it, and Izumi’s sushi is now sold in the canteen of Henty Public School. Subsequently “sushi girl” (as she is known in Henty), Izumi’s profession is a graphic designer came to the fore and last year, she designed and completed a wall mural behind a “buddy bench” or a “friendship bench” at Henty Public School - a bench that encourages students to play with those who are feeling lonely or have no one to play with.
Such a win/win for all was showing how with a good idea and persis-
» 48 FEBRUARY - MARCH 2023
THE FISHMONGER
tence you can make small steps to get to bigger goals.
The Fishmonger feels this could be taken further – taking the concept to other small towns and educating the kids and along with that the seafood industry could be assisting the process by bringing in an education process about seafood and the important health aspects of seafood consumption to mothers and children.
Just taking that a step forward The Fishmongers friend, Dr. Barry Costa-Pierce, recently commented on his LinkedIn profile ‘Aquaculture is very knowledge-based, so diverse, forever challenging, dynamic, innovative. Each day is a new discovery. My discovery of Norway continues. Farmed salmon is only ~50 years old. The first farmed salmon hit markets when I was a graduate student. In every place where aquaculture becomes an important part of a soci-
ety, a substantial investment in meaningful public education needs to be made. Not only in courses, social media, films, etc. but also by making significant investments in specific, dedicated, physical infrastructures and people to constantly engage the public in its dynamism! That’s where Norway stands alone in the world of aquaculture. Here in Bodø (Norway), “The Salmon Center” is right in in middle of town, open 7 days a week. And the amazing Domus Pisces aquaculture education center, , next to a school and small town nearby. Imagine what could happen if that was able to be done in other towns across the globe?Did you know that fourteen million meals of Norwegian farmed salmon are consumed every day across 110 countries? That was a fact learned from Barry’s comments… amazing, eh?
Back to the seafood and health subject - this year has seen a new re-
port emerge - Association of omega 3 polyunsaturated fatty acids with incident chronic kidney disease: pooled analysis of 19 cohorts. It covers the findings of an international team of researchers, which was led by the George Institute for Global Health and the University of New South Wales, where results were published in the medical journal the BMJ.
Chronic kidney disease (CKD) affects about 700 million people worldwide. It can lead to kidney failure and death, so there is a present and urgent need to identify factors that could prevent its onset and progression.
“While we cannot for certain say what specific fishes had the greatest effect on CKD risk, we know that the blood levels of the fatty acids reflect their intake well,” Dr Matti Marklund, a senior research fellow at the George Institute has reportedly said. He added “Among the richest dietary sources

» 49 FEBRUARY - MARCH 2023
of these fatty acids are fatty coldwater fish – for example, salmon, sardines, mackerel, and herrings – and, to a slightly less extent shellfish, like oysters, mussels, and crab.”
The findings support guidelines recommending consumption of oily fish and other seafood as part of a healthy diet. Eating at least two portions of oily fish a week is linked to a lower risk of chronic kidney disease and a slower decline in the organ’s function, the research suggests. “Current dietary recommendations in most countries suggest at least two servings of fish per week, preferably oily fish, which will provide about 250 mg/ day of long-chain omega 3s,” said Marklund.







Studies in animals have previously suggested omega three fatty acids may help with kidney function, but until now evidence from human research was limited – and relied mostly on dietary questionnaires but now this study has found an association between higher levels of omega 3 fatty acids found in oily fish and other seafood, and a reduced risk of kidney problems. The link was not found with higher levels of plantderived omega 3 fatty acids which goes along with the whole fish is best concept.
The researchers pooled the results of 19 studies from 12 countries examining links between levels of omega 3 fatty acids and the devel-
opment of CKD in adults. About 25,000 people were included in the main analysis, aged between 49 and 77. After accounting for a range of factors including age, sex, race, body mass index, smoking, alcohol intake, physical activity, heart disease and diabetes, higher levels of seafood omega 3 fatty acids were associated with an 8% lower risk of developing CKD.
When participants were split by levels of seafood omega 3 fatty acids consumed, those in the highest fifth had a 13% lower risk of CKD compared with those in the lowest fifth. Higher levels were also associated with a slower annual decline in kidney function. Results were similar
» 50 FEBRUARY - MARCH 2023 THE FISHMONGER
after further analysis and appeared consistent across age groups. “Higher levels were consistently associated with lower CKD risk,” he added.
These research outcomes need to be broadcast globally in any education program as prove that prevention is better than cure and that seafood is a key player.


John McFadden Update
In the Fishmongers last article there was a focus on John McFadden and how he brought all of his skills and unique experiences together to become the World Food Champion -Seafood and having won the sea-
food world title, Mr. McFadden now on his way to the Final Table event to be held in Bentonville, Arkansas, USA from 18th to 21st May 2023. He is practicing hard and has booked his accommodation and flights so we will keep you informed.

Meanwhile, John has become a Brand Ambassador for Yumbah Aquaculture, which has been announced as one of the 6 Finalists for the 16th Annual President’s Medal by Royal Agricultural Society of NSW (RAS). The only competition of its kind in Australia (maybe even globally), the RAS President’s Medal Award looks beyond product taste
and explores the overall production cycle of an award-winning business, from its commercial success and environmental footprint to its social and community impact.
To qualify for the President’s Medal, producers must have been a champion-winning product in the previous year’s Sydney Royal Wine, Dairy or Fine Food Shows, which means finalists have been selected from more than 4,000 entrants, 81 champions and from across 276 classes.
“The RAS President’s Medal is a unique award - not only does it allow us to judge an oyster producer against a dairy manufacturer, but it also lets us get down to the granular detail of how these businesses operate and to recognize them for that best practice and innovation. It is the only award in Australia that judges on a triple-bottom-line approach in the wine, dairy, and fine food industry,” Mr. Halmagyi, renowned chef, and President Medal judge, said.
In March this year, President’s Medal Judges, Ed Halmagyi and Michael Bullen will visit each finalist and conduct site tours to delve into the business’ commercial, environmental and social processes before announcing the 16th Annual President’s Medal winners at an event during the Sydney Royal Easter Show on Wednesday, 12th April. More success headed John’s way?
Is it me or has the world just become faster! It seems like only yesterday we were celebrating Christmas and New Year festivities and immediately we are seeing hot cross buns on sale in supermarkets. The need for planning ahead becomes more important in such a busy environment so be prepared.
References and sources consulted by the author on the elaboration of this article are available under previous request to our editorial staff.
» 51 FEBRUARY - MARCH 2023
aquaculture events
MARCH 2023
ACUICULTURA OFF-SHORE
March 13-29, 2023
Islas Canarias, Spain
T: +34 928 424 600
E: consultas@spegc.org
W: https://www.spegc.org/formacion-y-eventos/acuicultura-off-shore/
AQUAFUTURE SPAIN, INTERNATIONAL AQUACULTURE INDUSTRY SHOW
March 28-30, 2023
Santiago de Compostela, Spain
E: okeventos.juan@gmail.com
W: www.aquafuturespain.com
AQUASUR TECH 2023
March 29-30, 2023
Punta Arenas, Chile
T: +569 81888565
E: info@aquasur.cl
W: www.aquasurtech.cl/
APRIL 2023
PET FOOD AND AQUACULTURE EXTRUSION SEMINAR EXTRU-TECH / UABC
April 18-20, 2023
Ensenada, Baja California, Mexico
T: +1 (785)285 2637
E: igajardo@extru-techinc.com
W: https://www.etregistration.com/
LATIN AMERICAN & CARIBBEAN AQUACULTURE 2023 (LAQUA 2023)
April 18-21, 2023
Panama City, Panama
T: (+1) 760.751.5005 FAX (+1) 760.751.5003
E: worldaqua@was.org y carolina@was.org
W: www.was.org
SEAFOOD EXPO GLOBAL/SEAFOOD PROCESSING GLOBAL
April 25-27, 2023
Barcelona, Spain
E: sales-global@seafoodexpo.com; customerservice@divcom.com
W: https://www.seafoodexpo.com/global/
2nd REGIONAL CONGRESS ON AGRICULTURAL, FISH AND AQUACULTURAL PRODUCTION
April 26 – 28, 2003
Obregón City, Sonora, Mexico
E: ibs@potros.itson.edu.mx
FB: IBS ITSON
MAY 2023
4th COMPACT VIRTUAL COURSE IN AQUACULTURAL NUTRITION
May 16-17, 2023
VIRTUAL
T: (33) 8000 0629 Ext. 4758629
E: suscripciones@panoramaacuicola.com
W: https://panoramaacuicola.com
AGROTECH MÉXICO 2023
May 17-19, 2023
Guadalajara, Jalisco, Mexico
T: +52 55 7028 3335 ext. 823
E: maryann.delgado@hfmexico.mx rocio.andrade@hfmexico.mx
W: https://agrotechmexico.com/quienes-somos/
WORLD SEAFOOD INDUSTRY (WSI)
May 17-19, 2023
Guadalajara, Jalisco, Mexico
T: +52 473 756-0678; 52 (55) 7028 33 35
E: francisco.martinez@hfmexico.mx; thorsten.hofmann@hfmexico.mx
W: https://hfmexico.mx/worldseafood/
BLUE FOOD INNOVATION SUMMIT
May 23-24, 2023
Londres, United Kingdom
T: +44 (0) 1273 789989
E: james.reid@rethinkevents.com
W: www.bluefoodinnovation.com
12ª AQUISHOW BRAZIL
May 23-25, 2023
São José do Rio Preto, Brazil
T: (17) 99616-6638, (17)99181-3543
E: aquishow@aquishowbrasil.com.br
W: https://aquishowbrasil.com.br/
JULY 2023
AQUAEXPO EL ORO
July 11-13, 2023
Machala, Ecuador
T: (+593) 99 597-2885
E: gnivelo@cna-ecuador.com
W: www.aquaexpo.com.ec
AUGUST 2023
SHRIMP AQUACULTURE: REGENERATION
August 16-17, 2023
Bali, Indonesia
T: (65) 6327 8825/ F: (65) 6223 7314
E: conference@tarsaquaculture.com
W: http://tarsaquaculture.com
SEPTEMBER 2023
GLOBAL SHRIMP FORUM
Sept 5-7, 2023
Utrecht, Netherlands
W: https://www.shrimp-forum.com/
EXPOPESCA ACUIPERU/SEAFOOD LIMA
Sept 6-8, 2023
Lima, Peru
T: (511) 989-177-352
E: thais@thaiscorp.com
W: https://www.seafoodlima.com/
AERATION EQUIPMENT, PUMPS, FILTERS AND MEASURING INSTRUMENTS, ETC
DELTA HYDRONICS LLC.................................................................9
T: 727 861 2421
www.deltahydro.com
ANTIBIOTICS, PROBIOTICS AND FEED ADDITIVES
BAJA AGRO INTERNATIONAL.........................................................1
Privada Kino Este No. 100A-1 Parque Industrial Misión Ensenada, Baja California, Mexico CP 22830
www.yucca.com.mx
SÓMA..........................................................................................11
24, Hanbul-ro 69 Beon-gil, Eumseong-eup, Eumseong-gun, Chungcheongbuk-do 27698, Korea
E-mail : somafeednadditive@gmail.com
T: 043-878-0591
www.ssoma.co.kr
EVENTS AND EXHIBITIONS
AQUACULTURE AFRICA AFRAQ 2023........................INSIDE COVER November, 13-16, 2023.
Mulungushi International Convention Centre (MICC). Lusaka, Zambia.
Tel: +1 760 751 5005
E-mail: worldaqua@aol.com
www.was.org
AQUACULTURE AMERICA 2024................................INSIDE COVER February, 18-21, 2024.
San Antonio Marriot Rivercenter, San Antonio Texas.
Tel: +1 760 751 5005
E-mail: worldaqua@aol.com
www.was.org
AQUA 2024 BLUE FOOD / GREEN SOLUTION...........INSIDE COVER
August 26 - 30, 2024.
Copenhagen, Denmark.
Tel: +1 760 751 5005
E-mail: worldaqua@aol.com www.was.org
AQUA EXPO EL ORO 2023............................................................5
July 11-13, 2023.
Oro Verde - Machala, Ecuador.
Tel: +593 99 597 2885
E-mail: gnivelo@cna-ecuador.com www.aquaexpo.com.ec
WORLD AQUACULTURE............................................INSIDE COVER
May 29 to June 1, 2023.
Darwin Convention Centre. Darwin, Northern Territory, Australia.
Tel: +1 760 751 5005
E-mail: worldaqua@aol.com www.was.org
TANKS AND NETWORKING FOR AQUACULTURE
REEF INDUSTRIES.................................................BACK COVER
9209 Almeda Genoa Road Z.C. 7075, Houston, Texas, USA.
Contact: Gina Quevedo/Mark Young/ Jeff Garza.
T: Toll Free 1 (800) 231-6074
T: Local (713) 507-4250
E-mail: gquevedo@reefindustries.com / jgarza@reefindustries.com / myoung@reefindustries.com www.reefindustries.com
AQUACULTURE MAGAZINE............................INSIDE BACK COVER
Design Publications International Inc.
401 E Sonterra Blvd. Sté. 375 San Antonio, TX. 78258, USA
Office: +210 504 3642
Office in Mexico: +52(33) 8000 0578 - Ext: 8578
Subscriptions: iwantasubscription@dpinternationalinc.com
Sales & Marketing Coordinator
crm@dpinternationalinc.com | Cell: +521 33 1466 0392
Sales Support Expert sse@dpinternationalinc.com | Cell:+521 333 968 8515
PANORAMA ACUÍCOLA MAGAZINE
Empresarios No. #135 Int. Piso 7 Oficina 723
Col. Puerta de Hierro, C.P.45116 Zapopan, Jal. México Office: +52 (33) 8000 0578
Contact 1: Subscriptions
E-mail: suscripciones@panoramaacuicola.com

Office: +52 (33) 8000 0629 y (33) 8000 0653
Contact 2: Sales & Marketing Coordinator. crm@dpinternationalinc.com | Cell: +521 33 1466 0392
Contact 3: Sales Support Expert
E-mail: sse@dpinternationalinc.com www.panoramaacuicola.com
» 52 FEBRUARY - MARCH 2023 Upcoming
advertisers Index












 By Stephen G. Newman Ph.D. * President and CEO AquaInTech Inc.
By Stephen G. Newman Ph.D. * President and CEO AquaInTech Inc.





































 By: Aquaculture Magazine Editorial Team*
By: Aquaculture Magazine Editorial Team*





 By: Aquaculture Magazine Editorial Team*
By: Aquaculture Magazine Editorial Team*







 By: Amy Stone*
By: Amy Stone*